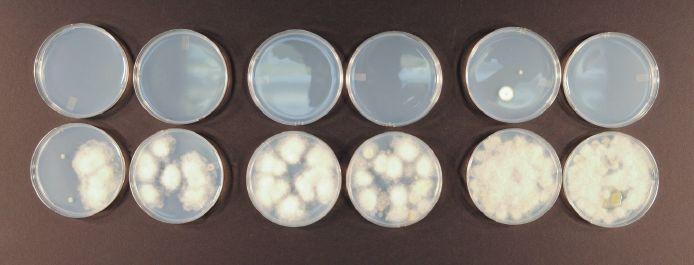

Competitive rivals back in the day, Santa Anita Park management honored the late, great Hollywood Park by naming its April 19-June 16 dates the spring “Hollywood Meet.” California-breds will be in the spotlight on Saturday, May 25, when the card features fve stakes, three of which were originally run across town and now are Santa Anita staples.
Originally created in the early 2000s as California Gold Rush Day, the state-bred spring showcase ofers a total of $550,000 in purses for the quintet of Golden State Series-eligible stakes.
Here’s the lineup:
ADDED VALUE, STAKES CONDITIONS, DISTANCE
$125,000 Snow Chief Stakes Presented by City National Bank
$125,000
Fittingly, each race is named after a champion Cal-bred from the past.
Preakness winner Snow Chief, bred by Carl Grinstead, owned in partnership with Ben Rochelle, and trained by Mel Stute, was the champion 3-year-old in the country in 1986. He was a three-time Cal-bred Horse of the Year, from 1985-87.
Melair, bred and owned by Marianne Millard and Bea Rous and trained by John Sadler, raced only fve times, all wins, capped by a defeat of Snow Chief when she ran the fastest mile for a female while beating the boys in the 1986 Silver Screen Handicap. She was named that season’s champion Cal-bred 3-year-old female and sprinter.
Tor’s Echo, bred by Fast Lane Farms, Carleton Block, and Harry Forman and trained by Doug O’Neill, was the second Cal-bred to win a Breeders’ Cup race as the upset winner of the 2006TVG Breeders’ Cup Sprint. He was voted an Eclipse Award as the nation’s champion sprinter of that season.
Crystal Water, wearing the silks of breeder/owner Connie Ring and trained by Roger Clapp, in 1977 reeled of consecutive wins in the Santa Anita Handicap, Californian, and Hollywood Gold Cup. Tat fall he added the Oak Tree Invitational. Crystal Water had been named Calbred Horse of the Year in 1976, when his wins included the Hollywood Derby, and he repeated with another Horse of the Year title in 1977.
Fran’s Valentine was bred by owner and auto paint entrepreneur Earl Scheib (“I’ll paint any car, any color for $29.95—no ups, no extras”) and trained by Joe Manzi. Named for Scheib’s wife, Fran’s Valentine won seven stakes, including the 1985 Kentucky Oaks. But she is equally remembered for the win taken from her, the controversial inaugural Breeders’ Cup Juvenile Fillies in 1984, when she fnished frst but was disqualifed and placed 10th for interference in the stretch. Fran’s Valentine was named a Calbred champion for four consecutive years.
626.445.7800
policies of the CTBA or this magazine. Publication of any material originating herein is expressly forbidden without frst obtaining written permission from California Thoroughbred. All advertising copy is submitted subject to approval. We reserve the right to reject any copy that is misleading or that does not meet with the standards set by the publication.
Acknowledgment: Statistics in this publication relating to results of races in North America are compiled by the Daily Racing Form Charts by special arrangement with Daily Racing Form Inc., the copyright owners of said charts. Reproduction forbidden.
OFFICERS
CHAIRPERSON
TERRY C. LOVINGIER
PRESIDENT
DOUG BURGE
VICE CHAIRPERSON
GEORGE F. SCHMITT
TREASURER
PETE PARRELLA
SECRETARY
SUE GREENE
DIRECTORS
John C. Harris, Gloria Haley, Pete Parrella, Sue Greene, Donald J. Valpredo, Terry C. Lovingier, George F. Schmitt, Ty Green, Justin Oldfeld, Adrian Gonzalez, Dan Harralson, Dr. Stacy Potter, Jonny Hilvers
ADMINISTRATIVE STAFF
CONTROLLER
THOMAS R. RETCHLESS
SALES
LORETTA VEIGA
REGISTRAR/INCENTIVE PROGRAM MANAGER
MARY ELLEN LOCKE
ASSISTANT REGISTRAR
DAWN GERBER
EXECUTIVE ASSISTANT/EVENT COORDINATOR
CHRISTY CHAPMAN
ADVERTISING MANAGER/PRODUCTION COORDINATOR
LORETTA VEIGA
WEBSITE MANAGING EDITOR
KEN GURNICK
LIBRARIAN/RECEPTIONIST/SUBSCRIPTIONS/ MEMBERSHIP
VIVIAN MONTOYA
RACETRACK LIAISON
SCOTT HENRY
California Thoroughbred (ISSN 1092-7328) is published monthly, except for two combined issues in June/July and Aug/Sept, plus one special issue in December, in Lexington, KY by Blood-Horse LLC, 821 Corporate Dr., Lexington, KY 40503.
Periodicals postage paid at Lexington, KY and at additional mailing offces.
POSTMASTER: Send address change to the 201 Colorado Place, Arcadia, CA 91007
Subscriptions - $55.00 per year USA $85.00 per year Canada & Mexico
EDITOR
TRACY GANTZ
COPY EDITOR
MARY SCHWEITZER
ART DIRECTOR
CATHERINE NICHOLS CREATIVE SERVICES DIRECTOR JENNIFER SINGLETON PRODUCTION FORREST BEGLEY ARTIST PHILIP TRUMAN
Fali Time, the California-bred Horse of the Year in 1983, won what was at that time the richest Toroughbred race ever, the Hollywood Futurity.




FIGHTING HUSSAR
Rockport Harbor – Lightning Pace, by Regal Classic Fee: $1,000 LFG

BIG RUNNUER
Stormy Atlantic – Elusive Luci, by Elusive Quality Fee: $1,500 LFSN

OSCAR NOMINATED
Kittens Joy – Devine Actress, by Theatrical (IRE)
Fee: $1,500 LFSN

MERIT MAN
With Distinction – Precise Strike, by Precise End
Fee: $1,500 LFSN

GATO DEL ORO
Medaglio D’oro – Funny Feeling, by Distorted Humor Fee: $1,000 LFG

ORIGINAIRE (IRE)
Zofany (IRE) - Polly Perkins (IRE) by Pivotal (GB) Fee: Complimentary

MO THE BEHOLDER
Uncle Mo – Leslie’s Harmony, by Curlin Fee: $2,500 LFSN

ROUSING SERMON
Lucky Pulpit – Rousing Again, by Awesome Again
Fee: $1,500 LFSN

KING OF JAZZ (ARG)
Giant’s Causeway – Kiss Me Sweet (ARG), by Lode
Fee: $1,000 LFG



A Full Service Thoroughbred Facility Centrally Located to All Southern California Racetracks
OFFERING
Breeding, Boarding, Mare & Foal Care, Lay-Ups, Breaking, Training, Sales Prep, 5/8 Mile Race Track
Marcos Menjivar, Manager 3001 W. Esplanade Ave Hemet, CA 92545
C (951) 316-5420
P (951) 654-9100
F (951) 654-9119
E: bgfarminc@gmail.com
California-breds
Only One America and Alotaluck won stakes at Sunland Park April 7. Only One America took the Island Fashion Stakes early on the card, followed by Alotaluck in the Mine Tat Bird Derby later in the day.
With Tracy Hebert aboard, Only One America led from the start of the one-mile Island Fashion to defeat odds-on favorite Deviletta by 514 lengths in 1:38.23. Todd Fincher trains 3-year-old Only One America for Kirk and Judy Robison.


Te Robisons bred Only One America, a daughter of Marking—Tat’s the Idea, by Diabolical. Only One America is a half sister to multiple stakes winner Competitive Idea.
Alotaluck, also ridden by Hebert, prompted the pace set by No Trouble in the 1116-mile Mine Tat Bird, ultimately defeating that
rival by 21⁄2 lengths in 1:44.53 as the odds-on favorite. Alotaluck had previously fnished second in the Riley Allison Derby and Sunland Park Derby (G3), in the latter to Stronghold, who went on to win the Santa Anita Derby (G1).
Ty Garrett trains Alotaluck for owner Eleanor Martin, his aunt. Martin bred Alotaluck, a 3-year-old gelded son of Sir Prancealot— Colinda Dawn, by Lucks Mine.
Daehling Ranch in Elk Grove, owned and operated by Justin and Julia Oldfeld, has partnered with Horses for Autism to ofer retirement services for Toroughbred racehorses. Daehling and Horses for Autism will ofer the opportunity for these horses to serve as equine therapists for the autism community. Horses for Autism is creating a Horses for Autism aftercare center, with the primary goal of giving retired Toroughbreds a second career in equine therapy and potentially ofering other vital services to the autism community. Plans are in motion to obtain accreditation from the Toroughbred Aftercare Alliance by 2025.

Horses for Autism transitioned into a non-proft entity under the George Noyes Foundation, a registered 501(c)(3) organization, in 2020. Prior to this, Horses for Autism has been a strong advocate in the autism community and has been raising autism awareness for more than 15 years through Toroughbred horse racing across the country.
“Our heartfelt thanks go to Justin and Julia for their invaluable support, which gives us the frst step towards working together in the best interest of both retired Toroughbred racehorses and the autism community,” said Johnny Taboada of the George Noyes Foundation.
$325,000
A California-bred daughter of Ghostzapper sold for $325,000 April 19 at the Ocala Breeders’ Sales Company’s spring sale of 2-year-olds.
Glen Hill Farm bred the flly, who is out of the Glen Hill homebred stakes-placed Maclean’s Music mare Consulting. Trainer George Papaprodromou bought the flly as agent from consignor Eddie Woods. A May 9 foal, the flly worked a furlong in :10. Glen Hill had sold the flly for $185,000 at the 2023 Keeneland September yearlings sale to Quarter Pole Enterprises LLC.
California-bred Johnny Podres won his second consecutive stakes by capturing the $100,000 Siren Lure Stakes at Santa Anita April 21. He followed his victory in the March 24 Sensational Star Stakes with the Siren Lure, both on the Santa Anita downhill turf course of about 61⁄2 furlongs.
Ridden by Geovanni Franco, Johnny Podres sat in fourth early in the Siren Lure. Te longest shot in the fve-horse feld at 16-1, he overhauled leaders First Peace and Lane Way in the stretch to score by a half-length in 1:11.57. First Peace fnished second, a length ahead of Lane Way.
Librado Barocio trains Johnny Podres for his Mia Familia Racing Stable and partner David A. Bernsen LLC. Barocio had claimed Johnny Podres for $40,000 in May 2023 from owner/breeder Nick Alexander. Johnny Podres was winning

his third consecutive race, beginning the streak for a $50,000 claiming tag with no takers.
“I think the key was when I dropped him in for $50,000 and he won—that gave him the confdence,” Barocio said.
Alexander bred Johnny Podres, a 7-yearold gelded son of Grazen—Malibu Holiday, by Harlan’s Holiday. Johnny Podres has earned a total of $482,870.
Five California stakes will continue to be a part of the Breeders’ Cup program Dirt Dozen. Comprised of 12 existing graded stakes races on dirt, the Dirt Dozen can earn horses credit toward entry fees for several 2024 Breeders’ Cup races on the dirt. This year’s Breeders’ Cup will be held Nov. 1-2 at Del Mar.
The California races that are part of the program are the July 27 San Diego Handicap (G2), Aug. 25 Rancho Bernardo Handicap (G3), and Sept. 8 Del Mar Futurity (G1) at Del Mar and the Sept. 28 Santa Anita Sprint Championship (G2) and Sept. 29 Zenyatta Stakes (G2) at Santa Anita.
Owners of horses fnishing frst, second, or third in the Dirt Dozen races may use credits earned toward entry fees for the Breeders’ Cup races on dirt. In Dirt Dozen races within the $2 million Breeders’ Cup race divisions, the bonus tier is $30,000 for frst, $15,000 for second, and $7,500 for third. In Dirt Dozen races in the $1 million Breeders’ Cup race divisions, the bonus tier is $15,000 for frst, $7,500 for second, and $3,750 for third.
The Breeders’ Cup has also increased the purses for the Breeders’ Cup Classic (G1) and Breeders’ Cup Turf (G1). The Classic will go from $6 million to $7 million, and the Turf from $4 million to $5 million.


Ten years ago, CALIFORNIA CHROME became the frst California-bred since Decidedly in 1962 to win the Kentucky Derby (G1). He stretched his winning streak to four consecutive stakes that day, May 3, 2014, which became fve when he added the Preakness Stakes (G1) May 17. Favored at 5-2 in the 19-horse Derby, California Chrome thrilled all of his “Chromies” when he took the lead with a quarter-mile to go and won the Run for the Roses by 13⁄4 lengths in 2:03.66 for 11⁄4 miles under jockey Victor Espinoza. Trainer Art Sherman said that he felt the Preakness was even more of a challenge, coming back in only two weeks, adding, “But he has a big heart this horse—big.” California Chrome won the Preakness by 11⁄2 lengths in 1:54.84 for 13⁄16 miles. Perry Martin and Steve Coburn bred the son of Lucky Pulpit—Love the Chase, by Not For Love, and California Chrome went on to be named that season’s Horse of the Year and champion 3-year-old male. He would win another Horse of the Year title in 2016 and was inducted into the National Museum of Racing Hall of Fame in 2023.
CLIQUOT, bred by Marshall Naify in California and owned by his 505 Farms, captured the $250,000 Snow Chief Stakes at Hollywood Park May 1, 1999. Emile Ramsammy piloted the 3-yearold gelding, who stalked the pace in third before making his move nearing the second turn of the 11⁄8-mile event. Favored at 8-5, Cliquot battled Red Sky’s through the stretch to edge that rival by a head in 1:50.27, with Love That Red third. Naify had co-owned champion Cal-bred Bertrando and bred Cliquot by crossing that stallion with the Lyphard mare Pharapache. John Shirreffs, who trained Bertrando for the last part of his career, also trained Cliquot. Naify died in 2000, and Cliquot later raced for the Thoroughbred Corporation in this country, fnishing his career in Saudi Arabia. He earned $673,246.
STARDUST MEL was in the middle of what would become a California-bred championship season when he won the El Dorado Handicap at Hollywood Park May 19, 1974. He went into the 11⁄16-mile
El Dorado off a victory in the Gold Rush Stakes at Golden Gate Fields. With Fernando Toro in the irons, the 3-year-old gelding defeated Shirley’s Champion by 31⁄2 lengths in 1:41, with Battery E. third. A $6,000 California Thoroughbred Breeders Association summer yearling sale purchase, Stardust Mel was the frst stakes winner owned by June and Larry Rose, and Larry Rose trained him. Marion Marsten bred the son of Wallet Lifter—Seems a Queen, by Berseem. Stardust Mel that year also won the Will Rogers Handicap (G2) and ran second in three other stakes, including the Hollywood Derby (G1). He was named the champion Cal-bred 3-year-old male of the season.

Owner-breeder Teresa McWilliams and trainer Alexis Barba, longtime friends, collaborated on California-bred UNUSUAL HEATWAVE to win the $100,250 Crystal Water Stakes at Santa Anita June 8, 2014. “Alexis has been my friend for over 30 years,” said McWilliams. Ridden by Kent Desormeaux, Unusual Heatwave outgamed Mega Heat and Ethnic Dance to score by three-quarters of a length in 1:34.17 for the mile on turf. McWilliams bred Unusual Heatwave, a 5-year-old son of Unusual Heat—Miss Alphie, by Candi’s Gold, and the mare also produced 2010 Sham Stakes (G3) winner Alphie’s Bet. Unusual Heatwave won the 2012 Snow Chief Stakes and Real Good Deal Stakes, and he earned $488,752. He was voted the 2012 champion Cal-bred 3-year-old male.

California-bred CHICHIM, in her stakes debut, came from behind after bobbling at the start to win the $100,000 Valkyr Handicap at Hollywood Park June 12, 1999. Jockey Garrett Gomez brought the 4-yearold flly on strongly in the stretch to power home by 31⁄2 lengths over Iza Bon Bon, Chichim getting the 51⁄2 furlongs on the turf in 1:02.12. Chichim, trained by Juan Garcia, would go on to add two editions of the California Cup Distaff Handicap and earn a total of $387,938. Bea Rous and Marianne Millard, who bred and raced Cal-bred champion Melair, bred and raced Chichim, a daughter of Chimineas—Chip’s Spirit, by Our Blue Chip. The flly was foaled at their Here Tis Ranch in San Jacinto.
California-bred MR. COCKATOO overcame a severe intestinal impaction as a 2-year-old and went on to become a stakes winner at 5 in the Rolling Green Handicap at Golden Gate Fields June 15, 1974. Dr. Joe Cannon had performed emergency surgery on the colt using a pile of straw between barns at Hollywood Park as an operating table. Mr. Cockatoo survived, though did not race at 2, and in the 11⁄2-mile Rolling Green he defeated multiple stakes-winning Kentuckian by a nose, stopping the timer in 2:284⁄5, with Yvetot third. Alvaro Pineda rode Mr. Cockatoo for trainer Jerry Fanning and owner Dan Agnew. Connie Ring bred Mr. Cockatoo, a son of Windy Sands—Miss Zenoda, by Count Fleet.







• Grade 3-placed winning son of Uncle Mo
• Out of a Graded Stakes producing Mineshaft mare
• Won debut for trainer Bob Baffert at Santa Anita by half a length over eventual Grade 3 Winner Hopkins
• Won next two starts




• Highest Equibase Speed Figure of 110 in the G3 Steve Sexton Mile Stakes
Martin Wygod, who stood several leading California sires at his River Edge Farm and bred and raced a string of top California-breds, as well as national champions, passed away April 12. A longtime board member of the Del Mar Thoroughbred Club, Wygod died at Scripps Hospital in La Jolla near his home in Rancho Santa Fe. He was 84.
Wygod and his wife, Pam, bred horses in Cal-


ifornia and Kentucky—a total of 124 stakes winners. They bred and raced Eclipse Award champion Sweet Catomine and her full sister Life Is Sweet, winner of the 2009 Breeders’ Cup Ladies’ Classic (G1). The second dam was the Cal-bred multiple stakes-placed Symbolically. From Symbolically the Wygods also bred Pirate’s Revenge, Cal-bred champion older female of 1995.
Born in New York City, Wygod went to high
and Graded
Pines G3 and the Cotillion Stakes G1
Dr. Schivel Spiced Perfection
Stakes Winner Sassy Nature
John Brocklebank (801) 885-9969
Randi Sackett at (916) 496-6559
Email: redcliffsracing@gmail.com

school with future Hall of Fame trainer Bobby Frankel and once walked hots at Belmont Park. After graduating from New York University, Wygod began his entrepreneurial career with another future California breeder, Fletcher Jones, founder of Westerly Stud. Wygod built Medco Containment Services into the nation’s largest mail-order prescription drug company, eventually selling it to Merck & Co. for $6.5 billion. Wygod later served as chairman of the board of directors of WebMD.
Jones gave Wygod his frst two horses, and when Wygod decided to build a farm in California, he bought land not far from Westerly in the Santa Ynez Valley. He hired Russell Drake to build and manage River Edge, and together they stood a string of top stallions, beginning with Pass the Glass, Bold Hitter, and Grenfall. But it was Pirate’s Bounty who really established River Edge as a force in California breeding.
Wygod bred the son of Hoist the Flag—Bad Seed, by Stevward, in Kentucky. Pirate’s Bounty won the 1979 Milburn Stakes at The Meadowlands and earned $95,984. After Pirate’s Bounty fnished racing, Wygod sent him to Drake at River Edge with instructions to stand him for $4,000. To support the stallion, Wygod told Drake to breed all of the 40-50 mares Wygod owned to him.
Pirate’s Bounty was an immediate success. Wygod bred the stallion’s frst graded winner, Wayward Pirate, winner of the 1984 Anoakia Stakes (G3) over Pirate’s Glow, another daughter of Pirate’s Bounty, and future Horse of the Year Lady’s Secret. Pirate’s Bounty was California’s leading freshman sire that season, and he led all California sires in 1992, 1994, and 1995. Wygod-bred runners by Pirate’s Bounty included Pirate’s Revenge and Bountiful Native, California-bred champion older female of 1992. Pirate’s Bounty was inducted into the California Racing Hall of Fame in 2011.
Stallions to stand at River Edge included Eclipse Award winner and Cal-bred Horse of the Year Bertrando, with the Wygods breeding Offcer, a son of Bertrando and a Cal-bred champion. Benchmark became another good River Edge sire, getting Eclipse Award champion sprinter and California-bred Horse of the Year Points Offthebench, Cal-bred champs Brother Derek and Bench Points, and current leading California sire Grazen.
Of the 32 graded stakes winners that the Wygods bred, they campaigned 21, including grade 1-winning Cal-breds Key Phrase, Silent Sighs, Unfurl the Flag, and Private Persuasion.
Wygod was a trustee of the Thoroughbred Owners and Breeders Association and a member of The Jockey Club since 1996. He joined the Del Mar board in 1999.
“Marty’s inclusion on our board proved to be a blessing over and over again,” said DMTC’s longtime CEO Joe Harper. “His insights and feel for both the world of business and our racing game helped us repeatedly make the kind of good decisions that have seen us rise to the top of the national racing community. We will dearly miss him.”
The following claiming levels for California owners premiums and stallion awards are currently in effect:





















To further assist the membership of the California Thoroughbred Breeders Association (CTBA) and subscribers of its offcial publication, California Thoroughbred, this monthly editorial page provides readers with updates about the association’s current policies, latest news, and upcoming events in the Golden State.
Te CTBA Sales Northern California Yearling & Horses of Racing Age Sale is scheduled for Tuesday, Aug. 13. It will be held at the Alameda County Fairgrounds in Pleasanton. Entries will close Friday, May 31.
For further information, contact Loretta Veiga at 626-4457800 ext. 227, or email loretta@ctba.com.
Te California Toroughbred Industry Directory is a great way to advertise your business. Cost for a full-page black and white ad is only $550. Be sure also to check your free directory listing to see that everything is correct and up-to-date. Deadline for inclusion is June 3.
For further information, contact Loretta Veiga at 626-4457800, ext. 227, or Loretta@ctba.com.
SEPT. 1—2024 Report of Mares Bred due from stallion owners/farms to California Thoroughbred Breeders Association
SEPT. 30—California-bred/California-sired registration deadline for foals of 2023 at $100 for CTBA members and $200 for non-members

DEADLINE TO ADVERTISE IS
The cost of a full page black & white ad is only $550
This is an inexpensive way to advertise your business, horse related or otherwise.
For information: Loretta Veiga (626) 445-7800, ext. 227 OR loretta @ctba.com
- 2025 Industry Directory
To further assist the membership of the California Thoroughbred Breeders Association (CTBA) and subscribers of its offcial publication, California Thoroughbred, this monthly editorial page provides readers with updates about the association’s current policies, latest news, and upcoming events in the Golden State.
To further assist the membership of the California Thoroughbred Breeders Association (CTBA) and subscribers of its offcial publication, California Thoroughbred, this monthly editorial page provides readers with updates about the association’s current policies, latest news, and upcoming events in the Golden State.






OFFICERS AND TRUSTEES
PRESIDENT
Ada Gates Patton
VICE-PRESIDENT/TREASURER
Gail Gregson
SECRETARY
Noreen Sullivan
Jeff Blea, DVM
Mary Forney
Tracy Gantz
Jane Goldstein
Thomas S. Robbins
John W. Sadler
Larisa Wick
Amy J. Zimmerman
Charlize Zuraek is the recipient of the California Toroughbred Foundation’s 2024 Western University of Health Sciences scholarship. Te Foundation awards scholarships to students at Western University as well as to students at the University of California, Davis. Tese extraordinary young people are training for a life of service to horses.
Ever since her mother adopted an of-the-track Toroughbred, Charlize has been interested in horses and was soon headed for her career goal of becoming an equine veterinarian. She competed in reining and was on the NCAA Division 1 Women’s Equestrian Team during the time she was doing her undergraduate work at U.C. Davis. She subsequently entered veterinary school at Western, where she expects to complete her degree in 2025.

Charlize has served veterinary externships with Starwood Equine Veterinary Services, Pioneer Equine Hospital, and two locations of the Steinbeck Peninsula Equine Clinics. As part of the annual convention of the American Association of Equine Practitioners held in San Diego, she participated in Del Mar Student Day to learn more about racetrack veterinary medicine. As president of Western’s student AAEP chapter, Charlize has planned several activities focused on racetrack veterinary medicine, including a dry lab, a podiatry lab, and a feld trip to the Fasig-Tipton yearling sale at Fairplex. She described the latter as “a club bonding event and to generate interest in the racetrack and/or equine industries.”
The CTF accepts donations in memory of relatives and friends, with all such donations allocated to Scholarship Funds of the Foundation. Please remember members of our industry with a donation to the CTF memorial fund. Donations may be sent to CTF, 201 Colorado Place, Arcadia, CA 91007.
The CTF joins in honoring the memory of those whose names appear in bold type. We also thank and acknowledge the donors for their generous contributions.
KATEY BARRETT
Gail Gregson
Sat, Jan 13
Sat, Jan 13
Sat, Jan 13
Sat, Jan 13
Sat, Jan 13
Sun, Feb 18
Mon, Feb 19
Sun, Mar 17
Sun, Mar 24
Sat, Apr 6
Sat, Apr 6
Sun, May 25
Sun, May 25
Sun, May 25
Sun, May 25
Sun, May 25
Sat, June 15
June
Sat, Oct. 5 October
Unusual Heat Turf Classic
Sunshine Millions F/M Turf Sprint
California Cup Derby
California Cup Oaks
California Cup Sprint
Spring Fever Stakes
Tiznow Stakes
Irish O’Brien Stakes
Sensational Star Stakes
Echo Eddie Stakes
Evening Jewel Stakes
Crystal Water Stakes
Snow Chief Stakes
Fran’s Valentine Stakes
Thor’s Echo Stakes
Melair Stakes
Mary Clare Schmitt Stakes
Bertrando Stakes
Fleet Treat Stakes
Real Good Deal Stakes
California Dreamin’ Stakes
CTBA Stakes
Graduation Stakes
Solana Beach Stakes
Generous Portion Stakes
I’m Smokin Stakes
Harris Farms Stakes
California Distaff Handicap
California Flag Handicap
Golden State Juvenile Fillies
Golden State Juvenile
Betty Grable Stakes
Cary Grant Stakes
Soviet Problem Stakes
King Glorious Stakes

Four-Year-Olds & Up
Four-Year-Olds & Up
Three-Year-Olds
Three-Year-Olds
Four-Year-Olds & Up
Four-Year-Olds & Up
Four-Year-Olds & Up
Four-Year-Olds & Up
Four-Year-Olds & Up
Three-Year-Olds
Three-Year-Olds
Three-Year-Olds & Up
Three-Year-Olds
Three-Year-Olds & Up
Three-Year-Olds & Up
Three-Year-Olds
Three-Year-Olds & Up
Three-Year-Olds & Up
Three-Year-Olds
Three-Year-Olds
Three-Year-Olds & Up
Two-Year-Olds
Two-Year-Olds
Three-Year-Olds & Up
Two-Year-Olds
Two-Year-Olds
Three-Year-Olds & Up
Three-Year-Olds & Up
Three-Year-Olds & Up
Two-Year-Olds
Two-Year-Olds
Three-Year-Olds & Up
Three-Year-Olds & Up
Two-Year-Olds
Two-Year-Olds
$200,000 $150,000 $200,000 $200,000 $150,000 $100,000 $100,000 $100,000 $100,000 $125,000 $125,000 $100,000 $125,000 $100,000 $100,000 $125,000 $75,000 $100,000 $175,000 $175,000 $150,000 $125,000 $125,000 $150,000 $125,000 $125,000 $75,000 $100,000 $100,000 $175,000 $175,000 $100,000 $100,000 $100,000 $100,000


Rusty Brown’s homebred Shady Tiger has consistently demonstrated to trainer Phil D’Amato that he has talent. Te 3-yearold California-bred gelding proved it defnitively in his frst stakes attempt when he captured the $127,000 Echo Eddie Stakes at Santa Anita April 6.
“Tis horse has done nothing wrong in the mornings,” D’Amato said.
Tose morning displays translated to wins as well. Second at Del Mar in his only start at 2, Shady Tiger is now a perfect three-for-three as a 3-year-old in 2024. He broke his maiden Jan. 7 on the dirt and then added a
conditioned race at six furlongs on the turf Feb. 17, both over six furlongs at Santa Anita.
Te 61 2-furlong Echo Eddie put him back on the dirt, and Shady Tiger handled the switch in surfaces with ease. He faced eight rivals and went of as the 3-1 second choice behind 5-2 favorite Tom Seaver, undefeated in two starts and out of Calbred champion Enola Gray.
Juan Hernandez has ridden Shady Tiger in all his starts and was back aboard.
Hernandez settled Shady Tiger into third behind leaders Prince Prancealot and Known Idea. Tom Seaver raced in ffth early and then moved up outside of Shady Tiger into third.
Tom Seaver took the lead between calls coming out of the turn. Hernandez swung Shady Tiger out fve wide to take aim on the leaders, running “right on by,” as announcer Frank Mirahmadi said, and coasting home by 51 2 lengths. Shady Tiger stopped the timer in 1:16.61. Longshot Stay On the Fence fnished a nose ahead of Two by Four in second, with Tom Seaver fnishing another length back in fourth.
“To be honest, he surprised me a little bit because on paper it looked like I was going to be too far back,” Hernandez said. “But today this guy brought his game. He broke really sharp, and I was just a couple of lengths behind the speed. I was in a perfect spot the whole race.”
D’Amato hopes to stretch out Shady Tiger in the future.
“He has impressed me, and I think he wants to go longer the way he galloped out today,” the trainer said. “We’ve been trying to get him to go in a two-turn race, but there really hasn’t been anything. Who knows? He might be able to compete against open company going long. He’s a nice horse, and I think he just keeps getting better and better.”
Brown has been a partner with Phil Lebherz and Alan Klein on many of the horses by Smiling Tiger, a multiple grade 1 winner and millionaire campaigned by Lebherz and Klein who now stands at John Harris’ Harris Farms in Coalinga. At the time of the Echo Eddie, Smiling Tiger was neck and neck with Clubhouse Ride for current-year leading sire honors among California stallions by purse earnings.

Premier Toroughbreds purchased the Full Mandate mare Divine Legacy in foal to Council Member for $6,000 at the 2014 Barretts January sale. Divine Legacy fnished second in the 2008 Bay Meadows Oaks and earned $168,448. Shady Tiger is the mare’s second winner in fve starters.



When European superstar jockeyFrankieDettorihada monster day at Santa Anita April 6, riding six consecutive winners,California-bredRoberta’sLove was part of his incredible day. Dettori began the skein in the second race, and piloted Roberta’s Love to victory in the $125,000 Evening Jewel Stakes for his third win. He added three more, including the Santa Anita Oaks (G2) aboard Nothing Like You.
Hall of Famer Bob Bafert, who trains Nothing Like You, noted that Dettori puts 100% into every ride, saying, “He’s just a phenom.” Roberta’s Love benefted from Dettori’s talent as well as his momentum.
Dettori hadn’t ridden Roberta’s Love in her two previous races. Tiago Pereira had partnered Roberta’s Love in her thirdplace debut Feb. 15 and her maiden victory March 17. But Pereira had also ridden the Grazen flly Safa in all of her eight starts, including a nine-length maiden score, and stuck with her.
Safa went of as the 2-1 second choice behind 6-5 Mirinda, a Cal-bred daughter of Mitole whose two starts, both last year, resulted in a 61⁄2-length tally and a third in the Golden State Juvenile Fillies Stakes. Grease Missle, a two-time stakes winner in from Turf Paradise, went of as the third choice in the six-horse feld, with Roberta’s Love the fourth choice at 9-1.
Roberta’s Love broke very well and took the lead in the frst few strides of the 61⁄2-furlong Evening Jewel.
“I was surprised,” Dettori said. “She jumped like a rocket and within 50 yards we were clear of the feld and at the rail.”
Clubhouse Bride got to within

a half-length outside of Roberta’s Love into the turn, pulling even with her before they reached the stretch. Roberta’s Love cut the corner and quickly put some distance between herself and Clubhouse Bride, only to have to fend of a closing Safa. But Roberta’s Love had plenty of energy and won by three-quarters of a length in 1:32. Clubhouse Bride held on for third.
“Tis flly is ultra consistent and was very well prepared,” Dettori said. “Tere were some good fllies in the race, but she put up a good performance.”
Hector Palma trains Roberta’s Love for owners BG Stables and Royalty Stable.
“Everyone was surprised to see her in front,” Palma said. “I really think this flly is going to go the distance. She’s been a great flly since the beginning.”
Richard Barton Enterprises bred Roberta’s Love in California, having purchased the dam, the Broken Vow mare West Coast Gal, for $4,100 at the 2016 Keeneland November sale in foal to New Year’s Day. Barton bred the mare to Collected to get Roberta’s Love and consigned the flly to the 2022 Fasig-Tipton California yearling sale. Palma purchased her there for $30,000.

“I really liked her body,” Palma said. “I looked at her and liked her. And the price was right.”
Barton was the leading California breeder in 2023 and is among the leaders again in 2024. West Coast Gal has produced four winners in four starters, including stakes-placed Yesterday’s News. She has a yearling colt by Game Winner.


A $500 travel allowance with a minimum purchase of $5000 is being offered to out of state trainers and trainers from Southern California who attend the upcoming 2024 Northern California Yearling and Horses of Racing Age Sale. Proof of travel is required.
Tuesday, August 13, 2024 at 12 PM Alameda County Fairgrounds, CA 94566
DEADLINE: MAY 31, 2024
DEADLINE: MAY 2024
CONTACT SALES COORDINATOR: Loretta Veiga: (626) 445 7800 Ext 227 or loretta@ctba.com

FALI TIME’S 1983 HOLLYWOOD FUTURITY WAS THE RICHEST OF ITS DAYBY TRACY GANTZ
Now that races around the world have multi-million-dollar purses, it’s somewhat quaint to think of a million-dollar race as being the richest race ever. But that’s just what Hollywood Park had in 1983 with the Hollywood Futurity (G1), and it was a California-bred, Fali Time, who won it.
Fali Time wouldn’t be the last Cal-bred to make headlines by winning big purses. Horses likeTiznow and California Chrome have fown the Cal-bred banner nationally and internationally. Four decades ago, however, Fali Time wasn’t supposed to be the horse standing in the winner’s circle.
Not that Fali Time didn’t have good credentials. Bred and owned by Jim Mamakos and Dr. Mark Stubrin, he was a son of Faliraki—First Time Out, by First Landing. Gary Jones trained Fali Time, and after breaking his maiden in his fourth start, the
colt captured the Norfolk Stakes (G1) at the Oak Tree meeting.
He won the 11⁄16-mile Norfolk at 18-1, defeating the flly Life’s Magic by a nose. She came from the D. Wayne Lukas formidable stable and would go on to earn two Eclipse Awards and win the 1985 Breeders’ Cup Distaf (G1).
Te Futurity feld attracted even more frepower. Life’s Magic returned, along with Althea, a Lukas flly who would be voted that year’s Eclipse Award as champion 2-year-old flly. Another future Eclipse




1) Fali Time defeated future Preakness winner Gate Dancer in the 1984 San Felipe Handicap
2) Sandy Hawley frequently piloted Fali Time during his career
3) Fali Time’s biggest win came in the 1983 Hollywood Futurity
4) To start his 1984 season, Fali Time captured the California Breeders’ Champion Stakes

Award winner in the feld was Precisionist, who would win the 1985 Breeders’ Cup Sprint (G1) and that year’s champion sprinter title.
Te week before the Futurity, Jones went skiing with Fali Time’s jockey, Sandy Hawley, which turned into a key strategy session.
“We were on the lift together,” Jones said, “and we mapped the whole thing out. I said, ‘Just get him running, leave him there, and get a good position. Tat’s the whole race going into the frst turn.’ And that’s what happened.”
Precisionist got worked up and took the early lead in the 11⁄16-mile Futurity, with Althea in hot pursuit. Hawley positioned Fali Time in fourth and waited for the leaders to falter. Tey did at the top of the stretch, and Fali Time came on to defeat another Cal-bred, Bold T. Jay, by a half-length in 1:413⁄5. Life’s Magic closed for third, with Althea sixth and Precisionist 10th.
Mamakos and Stubrin had bought First Time Out privately, and Mamakos had recalled Faliraki as a racehorse in explaining the breeding.
“He had brilliance, but he was also able to carry it over a distance of ground,” Mamakos said. “I think we’ve learned that if you’re patient with his foals and race them later in their 2-year-old year, that they will perform very well.”
FaliTime earned $549,849 for the Futurity, and he was voted that season’s Cal-bred
He was one of the sweetest little horses I’ve ever been around in my life. He just knew what you wanted him to do, and he’d do it.”
—Farrell Jones
Horse of the Year and champion Cal-bred 2-year-old male. He earned the 3-year-old male title the following year after capturing the California Breeders’ Champion Stakes and San Felipe Handicap (G1).
In the San Felipe, Fali Time defeated Gate Dancer, despite that horse bumping him. Gate Dancer would win that year’s Preakness Stakes (G1), but not before costing Fali Time his best chance in the Kentucky Derby (G1). Coming into the stretch of the Run for the Roses, Gate Dancer bumped Fali Time several times. Tey fnished fourth and ffth behind the winner, Swale, and Gate Dancer was disqualifed and placed ffth, moving Fali Time up to fourth.
After returning to his Hollywood Park headquarters, Fali Time nearly died of an intestinal blockage. Away from the races for several months, he returned to place in two more graded stakes and became a millionaire, but never won again.
Jones sent Fali Time to his father, retired trainer Farrell Jones, for some time of early in 1985. One night the colt became ill with colic, and his condition worsened too quickly for surgery. Fali Time died June 7, 1985, leaving behind people who would always remember him.
“He was one of the sweetest little horses I’ve ever been around in my life,” Farrell Jones said. “He never did anything you didn’t want him to do. He just knew what you wanted him to do, and he’d do it.”
Fali



The Following Breeders Awards are being held by the CALIFORNIA THOROUGHBRED BREEDERS ASSOCIATION for the following individuals:
Bada Beng Racing
Rusty Brown & Debi Brown
Michelle Casey
Ron Charles & Sam Gordon
Johnny Coito & Nicole DePalma, Rich & Joyce Osborne & Lee Treacy
Mauro Comensoli
C Punch Ranch Inc
Crown Racing Stables Ltd.
Daphne A. Daphne
Greg Davis
Bill Delia
Matthew Dohman
Double JH Stable, Inc.
Dunn Bar Ranch LLC
Equine Formula 1, LLC/Eric Yohan Knipe
Five J Racing
Harry Forman, Samuel Wenguer & Art Guglielmi
Michelle Friedman
Dennis Gellerman, Mersad Metanovic & Trevor Lottes
Frank Haverkamp
Estate of Bruce Headley & Simon Yu
Gus Headley & Paul Lenicheck
Juan Heredia
George Jacobs
Harry W. Jessup & Pacifc Coast Thoroughbreds, LLC
Kretz Racing LLC
Eric Yohan Knipe
Jason Litt
Kenji T. Morinaga
Martin Mueller, Davis Racing LLC & Take One Racing LLC
Nevada Equine LLC
2001 Offeld Family Trust
Alex Paszkeicz
Estate of Nancy Probert
The Estate of Charles P. Reilly
Skip & Zipp Racing LLC & Gilman Racing
Joe Stiglich & Lloyd Grant
Sunnyside Capital Ventures
Stuart Tsujimoto
Lidovina A. Wilson
George Yager & Art Sherman
Pamela C. Ziebarth
The checks will be released when proper identifcation is established.
Please contact Mary Ellen Locke or Dawn Gerber 201 Colorado Place, Arcadia, CA 91077 • (800) 573-2822 • (626) 445-7800 www.ctba.com
Joe Navarro has always loved horse racing lore. “Movies like ‘Seabiscuit’ and ‘Secretariat’ were important,” said Navarro, a California Toroughbred Breeders Association member since 2019. “Tey were great for horse racing and the country. We need stories like these in America today.”
Navarro, who considers racing his hobby, is trying to add to that inspirational list.
One horse story has grabbed the Texas native’s attention like no other: Never
Say Die—a near-dead newborn foal saved with a bottle of bourbon who became an international superstar. From that difficult beginning, the son of Nasrullah went on to win the 1954 Epsom Derby—the frst Kentucky-bred to accomplish the feat—and the St. Leger Stakes, the oldest of the British classics, by a whopping 12 lengths.
Tat was only a part of the amazing true tale as described in the 2013 book, Never Say Die, written by James C. Nicholson. Navarro calls the story “Seabiscuit on steroids.” It involves signifcant

touchstones, both for racing and popular culture, beginning with renowned Jonabell Farm, where the foal was saved by the quick thinking of owner John A. Bell III. Tere’s an 18-year-old jockey named Lester Piggott, who would go on to become perhaps the greatest rider in British history; Robert Sterling Clark, a wealthy heir to the Singer sewing machine empire; Queen Elizabeth II; the Casbah Cofee Club in Liverpool; and the band that would become the Beatles, to name just a few of the subplots.
Most of all, the book describes how Never Say Die, through his international exploits, helped revive the long-depressed Toroughbred breeding industry in the United States.
Navarro had one reaction after reading it: “Tis has got to be made into a movie,” and for the past fve years, he has been working on doing just that.
He has little experience in cinema. Since 1990, he’s owned USA Wire & Cable Inc., a global distributor of insulated copper electrical cables to the energy-producing industry. Navarro also owns Quattro Navarro Farms, his horse business previously known as Ranch 007.
A small-scale breeder who races horses mostly with trainer Doug O’Neill in California, Navarro and his wife, Stacia, split their time between a 50-acre farm on Lake Travis in Austin, Texas, and Lexington, Ky., where he has a 12-acre ranch “across the street from Spendthrift Farm.” A resident of Rancho
Santa Fe previously, he said he has also carved out time to attend the races each summer at Del Mar for the past 25 years.
Navarro bought the Lexington property a short time after attending the frst Breeders’ Cup held at Keeneland in 2015, saying he fell hard for the smalltown feel of Lexington, the racetrack, and the beautiful horse country surrounding the city. He learned of Never Say Die through Price Bell of Mill Ridge Farm, a famous bluegrass horse nursery where Navarro often sends his young horses.
Navarro has acquired the movie rights to Never Say Die and has been involved in discussions with potential producers. He has developed a “sizzle reel” and a pitch book to promote the movie project, which he estimates will cost about $10 million.
He spent a year co-writing a screenplay based on the book with an Austin friend, Mark Lehman, who was an experienced television screenwriter. Lehman unfortunately died last August, leaving Navarro to fnish the job. At the same time, Navarro has been in negotiations with LEX Studios in Lexington, a sister company of the Wrigley Media Group, for development and production assistance.
Navarro said he’s working toward the direction and casting of the flm, which he hopes can begin shooting later this year. He’s also encouraged by the reception he’s getting in Lexington.

racing in California and has a long association with Miguel Jimenez, former farm manager at Ballena Vista Farms and now at Arroyo Vista Farm.
Navarro currently owns two California-bred fllies and a colt, all by I’ll Have Another. Castagna is a 3-year-old flly out of the multiple stakes-placed Tribal Rule mare Family Girl. Her full sister, 4-yearold Illhaveanotherkiss, has one win in 10 starts with a second and two thirds. Illhaveanotherwon, a 4-year-old colt out of the Point Given mare Doctor Carina, is yet to start.

“When people found out I was doing this, they came out of the woodwork” to ofer support, he said.
Born in Houston, Navarro got started in racing at 16, owning parts of a few horses that raced in Louisiana for his grandfather. He eventually began
“She’s just getting started,” Navarro said of Castagna, which means chestnut in Italian. “I don’t race my horses until they are 3. And once they have shown they can run, I don’t race them too hard. Tat’s just the way I do it.”
Navarro has high hopes for American Only. A 4-year-old Kentucky-bred colt by American Pharaoh, he was out of the money in two starts going long on grass
in Kentucky in 2023 and has not started this year for O’Neill. Navarro paid $100,000 for the bay at the Keeneland yearling sale.
“I saw American Pharaoh win the Breeders’ Cup Classic (G1 in 2015), and I decided I had to have a colt by him,” Navarro said. “I call (American Only) my gentle giant. I just love the horse. I love the lineage.”
He’s also partnered with Tim Cohen of Red Baron’s Barn and Rancho Temescal and others on a couple of European-based mares acquired as future broodmare prospects.
One of those is Khinjani, a 4-yearold Great Britain-bred daughter of Sir Percy who has raced twice at Santa Anita this year for trainer Mark Glatt. She won her U.S. debut of the plane impressively in an optional claiming allowance with Frankie Dettori aboard Jan. 21. She returned to run third in the Santa Ana Stakes (G3T) Feb. 24.
Tey also bought Montjica, a Frenchbred 4-year-old flly who is expected to make her U.S. debut at Del Mar this summer. Also to be trained by Glatt, she is a daughter of Zoustar.
“I love turf horses and turf racing,” Navarro said. “I think it’s classier and I love the European way of racing.”
Questions and answers concerning California-breds and California’s lucrative incentive awards program, which was responsible for breeders, owners, and stallion owners collecting over $9 million for 2023.
Te breeders and owners of registered California-bred Toroughbreds and the owners of California-based stallions.
A monetary award that is paid to the breeder of a registered California-bred Toroughbred fnishing frst, second, or third in any Toroughbred only race run in California and any graded stakes races conducted within the United States. Breeders will receive 75% of the remainder of the total incentive award monies after owner awards are paid, with an individual breeder receiving a pro-rated share of this breeders fund. Te maximum purse considered earned in any qualifying race within this state shall be $330,000 for a win, $120,000 for a second, and $90,000 for a third-place fnish. Breeder awards always are paid exclusive of nomination, entry, and starting fees.
A monetary award that is paid to the owner of a registered California-bred Toroughbred horse that runs in qualifying races in California. Owners can receive at least a 20% bonus on the fnisher’s share for fnishing frst through ffth in an open allowance or overnight stake race and up to a 20% bonus for fnishing frst in an open starter allowance above $15,000 and open non-maiden claiming races with a claiming price of $40,000 or greater in Southern California and $20,000 or greater in Northern California. Tese levels are purposely set high to encourage the ownership of high-quality runners and to restrict the number of qualifers so that the awards will function as a major incentive. Owner awards always are paid exclusive of nomination, entry, and starting fees. Tey are listed in the racing program and will be distributed at the same time as the purse by the paymaster.
A Maiden Bonus award will be paid to the owner of a registered California-bred or registered California-sired foal for winning a Toroughbred only maiden special weight race. Te bonus amount is $15,000 at Santa Anita and Del Mar and $10,000 in Northern California, Los Alamitos and at all Fair meetings throughout the state. Tese awards are paid directly to the owner. Only races at 41 2 furlongs or longer will qualify. In the event of a dead heat, the bonus will be split among the owners.
In order to stimulate the acquisition in California of nationally prominent stallions, and retain high-caliber California stallions, monetary awards are paid annually to the owners of registered California stallions whose California-conceived or California-bred get have won a qualifying race or have fnished, frst, second, or third in a stakes race in the state or any graded stakes race within the United States during the year. Qualifying races are any non-claiming races, including maiden allowance and starter allowance races, with a purse of at least
$15,000, and open non-maiden claiming races with a claiming price of $40,000 or greater in Southern California and $20,000 or greater in Northern California also qualify. Stallion awards are exclusive of nomination, entry, and starting fees. Stallions must be registered by Feb. 15 each year to be eligible for stallion awards. Stallion owners will receive 25% of the remainder of the total incentive award monies after owners awards are paid, with an individual owner of a registered California stallion (as of Dec. 31) receiving a pro-rated share of the stallion fund based on the total qualifying earnings of the get during the year. Te maximum purse considered earned in any qualifying race within this state shall be $330,000 for a win, $120,000 for a second, and $90,000 for a third-place fnish. Te stallion must be continuously present in California from Feb. 1 to July 15, inclusive, of the year 2010 or any subsequent calendar year in which he stood at stud and fathered the participant in the race. If a sire dies in this state in the year 2010 or any subsequent year and stood his last season at stud in this state, or was standing at stud in this state on the date of his death in the year 2010 or any subsequent year, he shall thereafter continue to be considered an eligible Toroughbred stallion regarding a race participant fathered by him in that season. Te California Toroughbred Breeders Association (CTBA) will help compile data, but it is the ultimate responsibility of the stallion owner to advise that ofcial registering agency, on or before Feb. 15 of any year, of any and all purses earned during the preceding year that shall be considered in determining the amount of the stallion award to which the owner is entitled.
Yes. Te breeder of a California-bred Toroughbred fnishing frst, second, or third in a graded stakes race outside of California, but within the United States, will be paid a pro-rated share of the breeders fund. Te maximum purse considered earned in any race shall be $165,000 for a win, $60,000 for second, and $45,000 for a third-place fnish. CTBA will help compile data, but it is the ultimate responsibility of the breeder to advise the ofcial registering agency (CTBA), on or before Feb. 15 of any year, of any and all purses earned during the preceding year in graded stakes races outside of this state by horses bred by the breeder. Also, the owner of a registered California stallion whose California-conceived or California-bred get fnished frst, second, or third in a graded stakes outside of California, but within the United States, will be paid a pro-rated share of the Stallion fund with the maximum purse considered earned the same as the breeders above.
Owner awards are paid at the same time as the purse by the paymaster. Breeder awards are paid twice a year with a conservative advance payment of approximately 6-8% being paid around Sept. 1 and the fnal payment for 2024 being paid by March 31, 2025. Te stallion awards are paid prior to March 31, 2025.
ARE THERE SPECIAL RACING OPPORTUNITIES FOR CALIFORNIA-BREDS?
Yes. Racetracks in California are required by law to ofer one race per day that is restricted to California-breds. Last year, that amounted to 313 additional racing opportunities and more than $19.5 million in additional purses for California-breds. In addition, the California legislature has declared its intent that at least 10% of the total stakes purses paid at any race meeting in California be paid on stakes races restricted to registered California-breds. Tis amounted to more than 4.6 million in 2023 and will grow signifcantly through the creation of the Golden State Series. Also, in 2024, California Cup XXXV will be held at Santa Anita Park on a date to be announced. Part of the funding for California Cup XXXV will come from the incentive award category, the California-bred Race Fund. 9.5% of the total incentive award monies will be used for this category, with the monies funding the promotion of California-bred races, the supplement of purses for California-bred races, and the creation of new California-bred stakes.
WHAT IS THE DEFINITION OF A
Te defnition of a California-bred is as follows:
A California-bred Toroughbred is a horse dropped in California after being conceived in California, or any Toroughbred foal dropped by a mare in California if the mare remains in California to be next bred to a Toroughbred stallion standing in the state. If the mare cannot be bred for two successive seasons, but remains in California during that period, her foal will be considered a California-bred.
A “California-sired horse” is a Toroughbred that was conceived in California by a registered California stallion. A California-sired horse is only eligible for entry in races restricted to California-bred or Cali-
fornia-sired horses and is not eligible for any breeder or owner awards, except the maiden bonus awards.
HOW DOES ONE REGISTER A CALIFORNIA-BRED OR CALIFORNIA-SIRED HORSE?
Registration applications must be fled with the CTBA. Only those horses that are both registered with Te Jockey Club and fulfll all requirements as outlined in the defnition of a California-bred are eligible. Te fees for registration are as follows:
1. $100.00 for CTBA members, $200.00 for non-members if applied for by Sept. 30 of the foal’s yearling year;
2. $125.00 for CTBA members. $250.00 for non-members if applied for after Sept. 30 of yearling but before Jan. 1 following; and
3. $750.00 if applied for after Jan. 1 of 2-year-old year.
If desired, application can be made in advance of receipt of Jockey Club Certifcates to escape penalty for late fling, but no actual registration will be made until certifcates are available. CTBA has representation at California tracks to help facilitate late registrations.
Contact Doug Burge or Mary Ellen Locke at the CTBA ofces across the street from the Santa Anita Park racetrack in Arcadia at the address and phone numbers listed below.
California Toroughbred Breeders Association 201 Colorado Place, Arcadia, Calif. 90166-6018 www.ctba.com (626) 445-7800 or (800) 573-2822
Bob Abrams & Mitchell Dutko ......................$17,592.68
Barry Abrams, Dyan Bardy Farm & Huston Racing Stable.................................................................$418.19
Bob Abrams, Mitch Dutko & Michael Paran.....$9,513.70
Linda Adair & Julie Adair Stack ..........................$317.37
Adena Springs & Richard Barton Enterprises....$1,839.84
Gaylord Ailshie,David Bernstein & Sandy Weinstock ............................................................................$250.16
Frank Aldrich & Marysue Aldrich.....................$1,222.82
Allen Aldrich & Joe Nelson..............................$4,467.48
Frank Aldrich, Marysue Aldrich & Steven Miyadi .........................................................................$1,250.82
Sharon Alesia & Ciaglia Racing .......................$8,890.15
Sharon Alesia, Ciaglia Racing & Slam Dunk Stables .........................................................................$2,239.33
Sharon Alesia, Ciaglia Racing, Robin Christensen & Harry Crusberg..............................................$2,621.12
Nick Alexander...............................................$219,270.91
Michael Allen......................................................$1,008.12
Allen Farm.........................................................$11,211.45
Edward Allred.....................................................$8,890.15
Terry Amdur & Roxanna Amdur ......................$3,595.64
Jerry Anderson & Carol Anderson..................$1,592.47
Carol Anderson .....................................................$980.12
Nadine Anderson & Brazeau Thoroughbred Farms..... .........................................................................$3,080.38
John Antonelli .......................................................$522.73
Anna Marie Applegarth.......................................$659.02
Dr. John Araujo...................................................$5,376.65
Archa Racing.......................................................$2,884.35
Paul Atmajian......................................................$2,527.78
Wayne Atwell......................................................$1,275.09
M. Auerbach .......................................................$8,214.33
Vincent Augello..................................................$7,325.70
Dave Aurelio .......................................................$3,745.00
B & B Zietz Stables...........................................$12,926.39
Victor Bahna........................................................$2,641.66
Jerry Baker & Connie Baker .............................$2,632.32
Ballena Vista Farm .............................................$5,376.66
Bar C Racing Stables .........................................$8,206.50
Alexis Barba ........................................................$2,443.77
Gary Barber.......................................................$11,178.03
Gary Barber & Adam Wachtel.........................$5,096.62
Rozamund Barclay ...........................................$25,017.95
Rick Barker...........................................................$1,017.92
Baseline Equine..................................................$9,636.91
Dianne Bashor....................................................$3,491.10
Batchelor Family Trust..........................................$896.10
Barry Becker & Judith Becker ..........................$3,416.42
Ron Beegle .......................................................$12,123.61
Benowitz Family Trust........................................$1,461.77
Lisa Marie Bernard & Duff Shidaker................$4,178.11
Ed Bernstein & Andrew Molasky.....................$1,624.20
BG Stables.........................................................$24,518.99
BG Stables & Hector Palma .............................$1,508.07
BG Thoroughbred Farms .................................$2,621.12
BKB Stables.......................................................$15,243.66
BKB Stables, Jerry Haugg & Brenda Haugg ....$3,864.47
Black Racing Stable ..............................................$683.28
Blue Diamond Horseshoe...................................$298.70
Boone Family Trust, Arlyn Boone & Mike Boone ............................................................................$390.18
Keith Brackpool................................................$10,490.08
Keith Brackpool & Alice Bamford ...................$1,400.16
Allen Branch & Susan Branch .............................$750.49
William Branch & Arnold Hill............................$1,683.94
Ron Brewer & Mitchell Dutko ..........................$1,958.38
Patrick Brogan ....................................................$4,383.10
Brett Brophy & Kelly Dougan...........................$2,029.31
Greg Brous..........................................................$2,178.66
Rusty Brown ........................................................$5,316.92
Rusty Brown & Debi Brown ..............................$1,624.20
Perry Bruno & John Gezon...............................$3,215.92
Bulldog Racing & SGV Thoroughbreds.........$5,219.84
Vicky Burnham....................................................$4,592.56
C Punch Ranch, ................................................$24,906.24
California Chrome Syndicate, Harry K. Keshian, Cheryl Keshian & Paul K. Girdner ..............................$436.85
CalMont Thoroughbreds..................................$2,150.66
Stephen R. Campbell...........................................$442.46
Tom Capehart & William Myers ......................$1,663.40
Paula Capestro ......................................................$683.28
Kevin A. Carey .......................................................$343.51
Daniel A. Cassella ..............................................$2,168.59
James Cassidy & Alfred Saroni...........................$246.43 George J. Castanares...........................................$410.72 Chacon Racing. ..................................................$9,886.51 Mike Chainyk .........................................................$652.94
Thoroughbreds...........................$10,104.56
Checkmate Thoroughbreds, Hector Cuevas, Cuevaq-
Richard Cornwell...................................................$330.44
Craig Lewis Racing Stable, Elliot Lewis & Anapenny Racing.............................................................$2,064.78
Rob Creighton....................................................$7,457.90
Ron Crockett & Mr. & Mrs. William T. Griffn .$1,381.50
Crown Racing Stables .......................................$1,035.01
Cuevas-Montenegro Thoroughbreds............$1,619.07
D P Racing.........................................................$13,443.52
Daehling Ranch................................................$26,789.97
Dahlberg Farms..................................................$6,992.46
Dahlberg Farms.....................................................$418.19
Phil D'Amato & Tommy Hutton Dream Stables
$3,293.20
Daphne A. Daphne............................................$1,224.67
Pamela H. Davies ..................................................$151.22
Bob C. Davis .......................................................$2,418.01
Greg Davis..............................................................$989.45
Charlene Davis & Running Horse Equine Training Center................................................................$950.25
Rafael De Leon & Jaime Renella.....................$3,005.71
Dominic DeBellis & Michelle Rene DeBellis ....$504.06
Ed Delaney..........................................................$2,352.29
Bill Delia & Dr. Kim Kuhlmann.............................$784.10
Barbara Delima...................................................$6,104.74
Clifford DeLima, Barbara DeLima & Dennis Patterson
$3,462.16
Mark Devereaux & Scomar Enterprises .......$21,714.97
Sam Dilaura & Rozamund Barclay......................$459.26
Carol DiMaggio & Charles Fipke .......................$134.42
James Dixon .......................................................$1,194.81
Matthew Dohman..............................................$1,344.17
William Dory, Sandy Dory, Gary Kropp & Janet Kropp
$3,024.38
DP Racing..........................................................$35,651.56
DP Racing & James Cassidy ............................$3,528.43
Dunn Bar Ranch Llc............................................$2,766.74
Dunn Bar Ranch, Ray McCanna & Al Hodge $2,620.76
Charlie Dunn, Al Hodge & Ray McCanna .....$1,875.29
Mitchell Dutko & Bob Abrams ...........................$776.63
Erin T. Dwyer & David F. Reynolds ..................$1,624.20
Eagle Ridge Racing & Rancho San Miguel .$10,874.00
Terri Eaton & Joe Gibson .................................$5,427.25
Joel Eichenberger & Cathy Eichenberger........$151.22
Patricia Ann Elia Trust........................................$4,342.40
Julio Enciso .........................................................$7,680.04
Endless Summer Racing & Carr .........................$302.44
Robert Endow.....................................................$2,576.32
Jerry Engelauf.....................................................$5,638.02
Englekirk..............................................................$4,779.25
Equine Formula 1/Eric Yohan Knipe.............$17,193.19
John Ernst & Allegra Ernst................................$7,418.68
ESX Racing & Jorge Gutierrez.........................$6,071.14
Rayburn Evans ....................................................$1,411.37
Naseer Fasihuddin.............................................$2,441.89
Pete Fer ...............................................................$1,383.37
Carole Fernandez ..............................................$4,734.45
William Fishbough................................................$506.86
William Fishbough & Alyxandria Fishbough-Miller $1,258.29
Five J Racing..........................................................$224.03
Victor Flores ...........................................................$302.44
Melissa Ford........................................................$8,921.88
Fountain Of Youth Breeding............................$2,374.69
Four Quarters ...................................................$19,925.45
Randy Frank & Jeri Frank.....................................$476.99
Tanya Rae Freeman ...........................................$3,752.46
Cassie Freeman & Keenan Freeman..............$9,212.00
Michelle Friedman................................................$762.16
Larry & Robin Frost ............................................$6,370.23
W. Morgan Fussell & Joseph Wisner..............$4,777.77
Lori Gallegos.......................................................$2,990.77
Gallop Out Racing................................................$586.20
Jeff Ganje ..........................................................$10,378.81
James Georggin & Sonya Georggin..............$2,352.29
Gilman Racing ....................................................$1,120.14
Glen Hill Farm.....................................................$4,937.95
Marie L. Goda.....................................................$1,680.21
Josephine Deborah Goldberg...........................$561.94
Francisco Gomez ...............................................$4,893.13
Sergio Gonzalez....................................................$397.18
Roberto Gonzalez, Wright Batlin, Marc Batlin & Kathleen Parnello..........................................$5,596.77
Reina E. Gonzalez-Nelson & Jeff Kitchen......$2,548.31
Grasshopper Racing Stable,, Jack Fabulich & Jill Fabulich........................................................$13,928.90
Dr. & Mrs. William T. Gray...............................$35,098.20
Bob W. Grayson ...............................................$25,077.50
Dennis Grenier & Norine Grenier ...................$3,685.25
Mr. & Mrs. William T. Griffn..............................$1,881.83
Roy Guinnane.....................................................$2,520.30
Rolf H. Gustafsson..............................................$2,438.16
H & E Ranch......................................................$11,683.03
John R. Haagsma & Don Hallmark .................$5,201.15
Tom Halasz & Richard Brown...........................$6,218.62
Gloria Haley ...........................................................$324.84
Dwaine Lynn Hall & Eduardo L. Rich ..............$4,460.02
Halo Farms..........................................................$4,971.92
Timothy Hammer...............................................$3,995.15
Shirley Hansen & Mad Hansen Racing...........$1,116.40
Shirley L. Hansen, Mad Hansen Racing & Sandlot Racing Stables...............................................$7,553.67
Hanson's River Ranch......................................$10,155.57
Robert Harmon .....................................................$709.42
Patrick Harney & Charles Reilly........................$1,553.25
Daniel L. Harralson.............................................$1,669.94
Revocable Trust Of Dr. Mikel C. Harrington And Patricia O. Harrington .....................................$784.10
Harris Farms ....................................................$241,782.66
Harris Farms & Donald Valpredo.....................$8,061.25
Harris Farms & Double D Farms......................$2,118.93
Harris Farms & John Nicoletti........................$15,620.40
Harris Farms, Mike Lepore & Jeanne Lepore....$2,389.63
Bruce Headley....................................................$3,241.21
Karen Headley.......................................................$690.75
Bruce Headley & George Bolton....................$1,698.87
Bruce Headley & George Todaro ......................$750.49
Headley & Old English Rancho..........................$578.74
Gus Headley & Paul Lenicheck...........................$364.52
Headley, Todaro & Old English Rancho.........$2,161.87
William L. Hedrick & Judy Hedrick................$21,082.08
Robert Heinz & Michelle Machado....................$280.03 Scott Herbertson................................................$1,069.73
Jason Hall, Joe Wheeler and Herschel Martindale .........................................................................$4,159.45
Kathleen Kennedy ...........................................$17,547.68
William Kerr & Jared Kerr .................................$2,921.69
Dr. Dorothee Kieckhefer ...................................$5,667.89
Dr. Dorothee Kieckhefer & Leucadialand Stables ............................................................................$737.42
Al Kirkwood & Saundra Kirkwood...................$2,111.92
KM Racing Enterprise,..........................................$154.02
KMN Racing........................................................$6,913.28
Terry Knight.........................................................$1,030.53
Terry Knight, Jean Annuzzi & Mel Annuzzi ....$9,934.68
Kretz Racing Stable............................................$5,484.94
Darlyne Krieg......................................................$4,039.96
George Krikorian..............................................$63,814.38
Eric Kruljac, Tom & Rebekah Lawless .............$6,272.77
Dr. Kim Kuhlmann .................................................$151.22
Joseph LaCombe Stables & Eagle Ridge Racing ............................................................................$145.62
Frank P. Lagattuta...............................................$2,314.96
Curt & Lila Lanning ............................................$4,457.78
John Lanza .............................................................$627.28
Derek Lawson .....................................................$4,674.70
Valencia Leach & Godolphin ..............................$168.02
Legacy Ranch....................................................$28,590.76
Christine Level ....................................................$2,268.29
Liberty Road Stables........................................$30,538.94
Bob Liewald & Joe Mishak.............................$11,259.16
Lilley Ranch .........................................................$3,448.91
David Lindo............................................................$252.03
LNJ Foxwoods....................................................$5,996.11
Napoleon Lopez ................................................$1,525.26
Terry C. Lovingier ...........................................$201,932.23
Lynn, Michael & William Baker & Stormy Hull...$3,416.42
Janet K. Lyons.....................................................$2,975.82
Janet K. Lyons & Brian Koriner.........................$1,889.30
M & J Ranch Corporation.................................$6,696.56
Pat Maciariello....................................................$6,254.09
Madera Thoroughbreds ...................................$5,845.81
Madera Thoroughbreds & Dr. Patrick Golden .........................................................................$1,164.95
Madera Thoroughbreds & Glen Kjelstrom....$6,235.43
Linda Madsen...................................................$20,982.22
Linda Madsen & Joy Seifert .............................$2,085.79
Magee-Wolfson .................................................$1,192.95
Dale Mahlum ......................................................$1,288.16
Myles McMahon ..............................................$10,947.48
Matt Malley .........................................................$1,612.99
James Mann .......................................................$1,064.13
Jay Manoogian & Julie Manoogian ...............$6,272.77
Ernest Marchosky..................................................$134.88
Dean Marcic........................................................$2,987.03
Randy Marriott....................................................$1,129.47
Todd Marshall & Andrew Molasky ..................$6,804.84
Craig Martin........................................................$8,352.50
Perry Martin & Denise Martin ..........................$4,555.23
Jerry Martin & Margaret Martin.......................$5,458.07
Martin Bach.........................................................$6,353.60
Martin Bach & Daniel Weiner ........................$12,039.60
Kenneth Martindale & Andy Andrews ..............$840.10
Brett Mason ........................................................$5,578.29
Eileen Matson.....................................................$3,233.46
Ray McCanna......................................................$2,197.33
Patrick Mcdonnell ..............................................$1,194.82
David McGlothlin...............................................$2,507.99
Warren T. Mcgrath .............................................$2,818.64
Melody Conlon & Hector Palma.....................$4,181.84
John & Lu Mendenhall & Jim & Kathleen Walters .........................................................................$2,449.36
Carolyn Mendes....................................................$123.22
Tony Metaxas......................................................$1,006.25
Ken W. Miles & Sheridan Jones.....................$15,423.35
M. Millard ............................................................$3,445.82
Robert Mitchell.................................................$18,988.19
Moger, Inc. & Alan Eriksen ...............................$3,272.68
Moger, Inc. ..........................................................$1,400.17
Moger, Inc. & Andrew Miller ............................$2,106.62
Moger, Inc. & Neary Racing ...........................$14,584.18
Andrew Molasky...............................................$15,054.64
Michael Moran ...................................................$2,556.27
Joseph P. Morey Jr. Revocable Trust...............$4,665.38
Nina Morrow, Roberta Edwards & Ron Watchorn .........................................................................$2,053.58
Mike Mudaris......................................................$3,752.46
Martin Mueller, Davis Racing & Take One Racing .........................................................................$1,486.04
Donald Muldoon..............................................$12,419.87
Kristin Mulhall .....................................................$8,396.82
Cliff Naretto.........................................................$1,116.40
Michael Neumann & Francoise Dupuis .........$1,791.75
Louis Neve ..........................................................$4,990.20
Paul Lawrence Newhart ....................................$8,311.41
Michael Nicolarsen, Jeff Hauptman, Ron Hauptman & Walther Solis..................................................$3,382.82
Ali Nilforushan ..................................................$10,048.00
Kevin Nish ...........................................................$1,859.43
NP Thoroughbreds..........................................$10,775.44
Oak Hill Farm......................................................$2,645.40
Oakcrest Stable..................................................$4,312.17
J. Kirk Robison & Judy Robison.....................$39,353.20
Larry Odbert .....................................................$15,899.71
Mike O'Farrell.....................................................$4,872.58
Duane C. Offeld ...................................................$261.37
Old English Rancho.........................................$77,711.76
Old English Rancho & Bruce Headley............$8,322.61
Old English Rancho, Sal Berumen & Patsy Berumen .........................................................................$2,969.75
Francis O'Leary.................................................$39,249.36
Francis O'Leary & Paddy Brogan ....................$5,622.18
Timothy Francis O'Leary & Sean Molloy........$2,992.63
Robert Olivas & Jesse Montes ...........................$262.77
Daniel O'Neill ..................................................$31,915.61
David W. Osborne & Loren Hebel-Osborne....$3,416.42
Packsaddle Road ...............................................$3,545.24
Connie Pageler...................................................$9,856.08
Connie Pageler & Bob Baffert .......................$19,776.77
Philip Carlyle Paine ............................................$2,285.07
Alfred A. Pais.....................................................$16,954.18
Alfred Sonny Pais & Rainmaker Racing..........$2,800.35
Papa Gallo Racing ................................................$604.87 Paradox Stable ...................................................$2,434.44
Steve Pavich & Meritage...................................$3,461.97 Pay Me Stables...................................................$5,499.87
Bud Petrosian ........................................................$660.88
Policzer.........................................................$5,210.50
De Los Aviadores, Sacha Campbell & David Chase...............................................$2,202.93
Rancho San Miguel............................................$6,093.54
Rancho San Roberto & Siena Spasiano ............$810.23
Ron Rand & Courtney Rand.............................$8,156.46
Richard
Charlie Robin ......................................................$2,114.82
Jim Robinson......................................................$3,350.15
Clay W. Robinson, DVM....................................$7,727.08
Rockingham Ranch..........................................$13,734.39
Rockingham Ranch & Peter Miller .....................$242.70
Leove Rodriguez ................................................$3,252.14
Rollercoaster Racing Stable .............................$1,556.62
Curt Rollins..........................................................$9,250.09
Raul Rosas ..............................................................$327.64
Michael Rovner & Glen Wallace......................$1,753.77
Nat Rubinfeld & Alma Rubinfeld........................$541.40
Ruis Racing........................................................$24,756.50
Running Horse Training Center.......................$8,128.94
Mike Ryan............................................................$3,603.10
SAF Racing, Ciaglia Racing & H. Crusberg ...$6,590.04
Sergio Salguero.....................................................$190.42
Armando Sanchez .............................................$3,024.36
Sanguinetti 1996 Trust..........................................$700.09
Say Jay Racing....................................................$2,479.23
Say Jay Racing & Beerman Family Trust ......$10,686.11
Say Jay Racing & Kurt Rexius..............................$224.03
George Schmitt & Mary Clare Schmitt.........$17,301.19
George Schmitt, Clare Schmitt & Bernie Orsi$1,232.15
George Schmitt, Mary Clare Schmitt & Bernie Orsi, Rich Meister ...................................................$3,632.97
George Schmitt, Mary Clare Schmitt & Larry Frost .........................................................................$2,445.62
George Schmitt, Mary Clare Schmitt & Richard Meister............................................................$3,735.66
George Schmitt, Mary Clare Schmitt & Steve Cline ............................................................................$388.32
George Schmitt, Mary Clare Schmitt, Anthony Bilich & Steve Cline........................................................$466.72
Schroeder Farms................................................$1,861.76
Eric Schweiger, Gordon Jarnig & Kenny Marshall .......................................................................$14,318.60
Seamist Racing...................................................$7,917.51
Shanderella Stables & Mark Cohen...................$770.56
Mr. & Mrs. Thomas A. Shapiro.......................$18,889.25
George Sharp.....................................................$9,308.34
Ken Shaw, Robert Traynor, Ernest Marchowsky, Lo Hi Stable et al..............................................$252.03
James Shenouda ...............................................$1,101.46
James Shenouda & Alfred A. Pais ..................$5,197.43
Ernest Sherman.....................................................$224.03
Art Sherman & Zvika Akin.................................$3,132.65
Turner Shiew .......................................................$2,972.10
Howard & Janet Siegel Racing...........................$178.76
Silver State Racing .............................................$1,112.67
Six-S Racing Stable............................................$9,285.93
SJS Stables..........................................................$4,317.19
SLO Racing Stable...........................................$21,773.58
Leslie M. Smith ...................................................$1,418.84
Donald C. Smith & Gloria Haley Smith ..........$1,344.16
Special T Thoroughbreds....................................$750.49
Phil Stathatos .........................................................$511.53
Heinz H. Steinmann...........................................$4,233.37
Stepaside Farm .....................................................$666.48
Megan Stiehr ......................................................$7,752.12
Mike Stiehr & Megan Stiehr................................$930.65
Joe Stiglich & Lloyd Grant...................................$918.52
Straight Fire.......................................................$22,574.13
Andrew Stronach ...............................................$1,853.82
Thomas Stubblefeld.........................................$1,935.59
Steve E. Swanson..................................................$952.12
Edward Tannenbaum........................................$2,092.80
Norman Tavares .................................................$6,351.17
Gene Tenbrink....................................................$7,671.08
Gene Tenbrink & Frank Ables..........................$1,235.88
The Quarter Company......................................$3,967.15
G. W. Thomas .....................................................$5,647.74
Thomas W. Bachman ......................................$29,151.33
Three Amigos Racing...........................................$335.11
Jim Tilton.............................................................$3,733.79
Tiz Molly Partners.............................................$45,610.84
George Todaro...................................................$4,211.71
Tommy Huttons Dream Stable........................$2,118.47
Tommy Hutton's Dream Stable & Queen Bee Racing ............................................................................$784.10
Tommy Town Thoroughbreds .......................$44,603.65
Robert Traynor..................................................$11,565.40
Robert Traynor & Lo Hi Racing Stable............$5,003.28
Triple AAA Ranch...............................................$1,001.13
Matthew Troy.........................................................$173.62
Stuart Tsujimoto ...............................................$15,961.95
Joe Turner ...........................................................$2,254.56
Donald Valpredo..............................................$28,870.42
Mr. & Mrs. Donald Valpredo.............................$1,530.85
Agustin Velazquez..............................................$6,688.71
Victory Rose Thoroughbreds .........................$27,708.47
Victory Rose Thoroughbreds & KMN Racing....$6,486.70
Victory Rose Thoroughbreds, Jerry Martin & Margaret Martin ........................................$1,674.23
Victory Rose Thoroughbreds, John Pennant Jones,
Donald Wollan & Tim Foley........................$2,440.03
Jim Volk................................................................$3,920.48
Doug Walker & Keith Fosness.........................$1,176.15
Patricia Wall & Bill Delia ....................................$4,060.50
Lisa Wall, Perry Martin & Denise Martin............$257.63
Eric M. Waller & Sharon J. Waller....................$5,029.41
Warlock Stables and Perry and Denise Martin.....$451.79
Benjamin C. Warren & Sally Warren .............$19,133.79
Benjamin Warren, Sally Warren, Rainmaker Racing & Brett Lewis.....................................................$918.51
Watchorn, Morrow & Fast Lane Farms...........$3,819.66
Thomas M. Weckerle & Roberto Gonzalez...$2,923.56
Mike Weeks, Linda Weeks & Devyn Weeks...$21,795.99
12 Ranch..................................................$10,318.72 Cynthia White.....................................................$2,184.27 Brett Wiener & Lawrence Kahlden..................$1,241.49
35
36
Acclamation—Reba Is Tops: Rebalation (28-13), m, 8 yo, Santa Anita Park, STR, 4/19, 5 1/2f (T), 1:02.80, $28,800.
Cat Burglar—Moonie: Left Hand Man (26-11), c, 4 yo, Santa Anita Park, AOC, 4/6, 6f, 1:10.05, $40,200.
Cat Burglar—Distant Memories: Idaho Once (26-11), g, 4 yo, Golden Gate Fields, ALW, 4/12, 6f, 1:10.27, $18,330.
Clubhouse Ride—Alphabet Kisses: Kiss Ride Goodbye (60-20), m, 7 yo, Fonner Park, STR, 3/29, 6f, 1:13.80, $3,840.
Collected—West Coast Gal: Roberta's Love (96-38), f, 3 yo, Santa Anita Park, STK, Evening Jewel S., 4/6, 6 1/2f, 1:16.83, $75,000.
Curlin to Mischief—Just Lookn Again: Lmlooknformischief (31-12), g, 5 yo, Golden Gate Fields, AOC, 4/13, 5 1/2f, 1:03.88, $12,480.
Danzing Candy—Temper: Diamonds Danzing (47-18), f, 4 yo, Santa Anita Park, AOC, 4/4, 6 1/2f, 1:17.06, $40,200.
Far From Over—Dustkickin Lass: Dust Maker (16-6), f, 4 yo, Turf Paradise, AOC, 4/2, 1mi, 1:37.06, $19,220.
Finnegans Wake—Brilliant Melody: Mogollon Rim (5-3), g, 5 yo, Golden Gate Fields, ALW, 4/13, 1mi, 1:37.92, $18,330.
Gig Harbor—Smarty Corn: Kerry Gold (16-9), g, 5 yo, Turf Paradise, AOC, 4/16, 1mi (T), 1:34.18, $18,585.
Grazen—Spiced Latte: Grazen in the Sun (65-21), m, 5 yo, Santa Anita Park, ALW, 4/7, about 6 1/2f, 1:12.89, $40,200.
Grazen—Malibu Holiday: Johnny Podres (65-21), g, 7 yo, Santa Anita Park, STK, Siren Lure S., 4/21, about 6 1/2f, 1:11.57, $60,000.
Heatseeker (IRE)—Madame Heat: Heat N Reheat (3-2), g, 7 yo, Turf Paradise, AOC, 4/9, 1mi, 1:35.95, $18,900.
He Be Fire N Ice—Cause Ur My Babe: Oubabe (9-3), h, 5 yo, Santa Anita Park, AOC, 4/21, 1 1/8mi (T), 1:48.75, $33,000.
Idiot Proof—Sizzling Gold: Idiot's Gold (17-7), g, 5 yo, Golden Gate Fields, STR, 4/14, 5f, 57.26, $11,880.
Indian Evening—Anger: Gayles Evening (3-2), m, 6 yo, Gulfstream Park, SOC, 4/19, 5f, 56.67, $16,800.
James Street—Grantmartyamiracle: Dirt Flirt (5-3), m, 7 yo, Turf Paradise, AOC, 3/25, about 1mi, 1:37.19, $19,215.
James Street—Grantmartyamiracle: Dirt Flirt (5-3), m, 7 yo, Turf Paradise, AOC, 4/3, about 1mi, 1:37.29, $19,825.
Jersey Town—Sing and Tell: Town Performer (15-5), g, 4 yo, Golden Gate Fields, AOC, 4/21, 5f (T), 56.90, $18,330.
Jimmy Creed—Intimate Obsession: Victim of the Nite (75-26), g, 4 yo, Parx Racing, STR, 4/9, 6 1/2f, 1:19.39, $19,200.
Kitten's Joy—Pretty Hard: Aligato (115-25), g, 7 yo, Santa Anita Park, AOC, 4/6, 1mi (T), 1:33.84, $52,260.
Many Rivers—Shes a Lucky Wager: Poker Alice (11-6), f, 3 yo, Golden Gate Fields, STR, 3/29, 1mi, 1:40.77, $11,880.
Marking—That's the Idea: Only One America (42-16), f, 3 yo, Sunland Park, STK, Island Fashion S., 4/7, 1mi, 1:38.23, $77,500.
Nyquist—Taffeta: Dont Fight the Fed (126-34), c, 4 yo, Santa Anita Park, AOC, 4/5, 1mi, 1:37.88, $40,200.
Run Brother Ron—Rutters Renegade (IRE): Two Bills (4-3), g, 8 yo, Los Alamitos, WCL, 4/13, 4 1/2f, 51.02, $5,740.
Sharp Azteca—Transact: Deo (92-25), g, 4 yo, Golden Gate Fields, STR, 4/20, 1mi (T), 1:37.22, $10,890.
Sir Prancealot (IRE)—Colinda Dawn: Alotaluck (31-10), g, 3 yo, Sunland Park, STK, Mine That Bird Derby, 4/7, 1 1/16mi, 1:44.53, $75,000.
Slewcious—Asong for Cynthia: North Country (2-1), g, 4 yo, Golden Gate Fields, STR, 4/7, 6f, 1:10.87, $10,890.
Smiling Tiger—Seekitana: Imperial Hornet (84-27), g, 4 yo, Golden Gate Fields, SOC, 3/30, 6f, 1:10.57, $6,900.
Smiling Tiger—Finish Rich in Nyc: Broadway Tiger (84-27), f, 3 yo, Golden Gate Fields, STR, 3/31, 6f, 1:11.05, $11,880.
Smiling Tiger—Perfect Rhyme: Tiger Queen (84-27), m, 7 yo, Golden Gate Fields, SOC, 4/6, 5 1/2f, 1:04.31, $7,500.
Smiling Tiger—Divine Legacy: ShadyTiger (84-27), g, 3 yo, Santa Anita Park, STK, Echo Eddie S., 4/6, 6 1/2f, 1:16.61, $75,000.
Square Eddie—Loan Savant: Eddie's Last (31-14), g, 4 yo, Santa Anita Park, SOC, 4/5, 6 1/2f (T), 1:14.97, $27,360.
Square Eddie—Little Treasure (ITY): Where's Frankie (31-14), m, 6 yo, Turf Paradise, WCL, 4/8, 5f, 56.66, $8,120.
Stanford—Wicked Factor: Captivated Drama (61-25), g, 4 yo, Will Rogers Downs, ALW, 4/3, 5 1/2f, 1:04.05, $15,000.
Stanford—Kathleen Rose: Man O Rose (61-25), g, 4 yo, Santa Anita Park, AOC, 4/20, 6 1/2f, 1:15.25, $42,900.
Stay Thirsty—Smiling Tigress: Buraq's Refection (103-30), g, 3 yo, Turf Paradise, AOC, 4/17, 1mi (T), 1:36.33, $18,910.
Sway Away—Jumanah: Windribbon (10-6), g, 8 yo, Turf Paradise, AOC, 3/27, 6f, 1:09.45, $20,130.
Tamarando—Angel Diane: Tam's Little Angel (21-9), m, 5 yo, Golden Gate Fields, AOC, 3/31, 1mi, 1:37.45, $18,720.
Tamarando—Halo Darlin: Halo Rando (21-9), g, 3 yo, Golden Gate Fields, AOC, 4/20, 5 1/2f, 1:03.36, $18,330.
Tamarkuz—Bonus Spin: Go Go Sadie (39-15), m, 5 yo, Turf Paradise, AOC, 4/3, 6f, 1:08.14, $19,200.
Tiz a Minister—Hurricane Tiz: Tizzy Twister (4-3), m, 5 yo, Santa Anita Park, AOC, 3/29, 1mi, 1:39.19, $40,200.
Tom's Tribute—Lady Katfsh: Ecologist (9-4), g, 7 yo, Golden Gate Fields, SOC, 3/31, 1mi, 1:38.99, $6,900.
Tom's Tribute—Shot In The Sun (IRE): Five O Cocktail (9-4), f, 4 yo, Golden Gate Fields, AOC, 4/6, 6f, 1:10.02, $12,220.
Unionize—Rachels Belle: Miss Union (6-4), m, 5 yo, Turf Paradise, AOC, 3/26, 6f, 1:09.59, $20,130.
Unusual Heatwave—Limited Passion: Limited Heatwave (6-1), g, 6 yo, Turf Paradise, AOC, 4/3, about 1mi, 1:37.01, $18,600.
Carpe Diem—Algorhythmic: Runnin Ute (70-26), g, 3 yo, Golden Gate Fields, MSW, 3/31, 5 1/2f, 1:04.66, $17,550.
Clubhouse Ride—Lamazone: Moment's Pleasure (60-20), f, 3 yo, Santa Anita Park, MSW, 4/6, 6f (T), 1:09.55, $39,000.
Clubhouse Ride—Wild Caroline: Quantum Innergy (60-20), f, 3 yo, Santa Anita Park, MSW, 4/21, 1mi (T), 1:36.35, $32,400.
Coach Bob—Cinderella Liberty: Last Baby (7-2), c, 3 yo, Golden Gate Fields, MCL, 4/12, 6f, 1:12.31, $6,600.
Dads Caps—Noise of the Crowd: Discreet Mob (29-8), g, 3 yo, Sunray Park, MSW, 4/14, 4 1/2f, 52.36, $12,900.
Danzing Candy—Cool Munnings: Along Came Joann (47-18), f, 4 yo, Golden Gate Fields, MCL, 4/5, 1mi, 1:40.80, $7,200.
Danzing Candy—Star Field: Mars Magic (47-18), f, 3 yo, Golden Gate Fields, MSW, 4/5, 1mi, 1:40.05, $17,550.
Danzing Candy—Sweetest Secret: Embraceable You (47-18), f, 3 yo, Golden Gate Fields, MSW, 4/7, 6f, 1:11.62, $17,550.
Danzing Candy—Helluva Hooley: Ryder's Candy (47-18), m, 5 yo, Santa Anita Park, MSW, 4/19, 5 1/2f, 1:05.88, $32,400.
DESERT CODE Harris Farms (800) 311 6211 www.harrisfarms.com
Desert Code—Call Betsy: Betsy Is the Code (14-8), f, 4 yo, Turf Paradise, MCL, 4/4, 4 1/2f, 51.72, $7,080.
Gem Heist—Lady Comic: Carol's Comic (3-2), g, 5 yo, Santa Anita Park, MCL, 4/21, 6 1/2f, 1:18.07, $11,400.
Gig Harbor—Dahlia Dearest: Harbor Dearest (16-9), f, 4 yo, Golden Gate Fields, MCL, 4/5, 5f, 59.81, $5,500.
Grazen—Anita's Cookin: Juliet's Kitchen (65-21), m, 5 yo, Golden Gate Fields, MCL, 4/7, 5 1/2f, 1:05.10, $6,300.
Grazen—Sun Belt: No Show Jones (65-21), g, 3 yo, Los Alamitos, MCL, 4/20, 4 1/2f, 52.85, $3,930. Grazen—Freedom Ride: Travelin' Show (65-21), g, 3 yo, Santa Anita Park, MSW, 4/20, 6f (T), 1:09.67, $32,400.
He Be Fire N Ice—Wild Phoebe: Moon Ice (9-3), g, 4 yo, Santa Anita Park, MSW, 4/20, 6f (T), 1:08.92, $32,400.
Idiot Proof—Ghost N Your Heart: Adios Nicanor (17-7), g, 5 yo, Golden Gate Fields, MSW, 3/30, 6f, 1:10.89, $17,550.
Klimt—Princess Hillary: Princess K (105-35), f, 3 yo, Turf Paradise, MCL, 4/10, 5f, 58.84, $9,000. Lakerville—Strawberry Tart: Sweet Laker (16-7), f, 4 yo, Golden Gate Fields, MCL, 4/21, 5 1/2f, 1:05.74, $6,600.
Many Rivers—Ambitoness: River of Ambition (11-6), f, 3 yo, Golden Gate Fields, MCL, 4/6, 5 1/2f, 1:05.61, $6,300.
Many Rivers—Marketable: River Market (11-6), f, 3 yo, Golden Gate Fields, MCL, 4/12, 1mi, 1:41.07, $6,300.
Mr. Big—Steamy Novel: The Big Cheeseola (44-15), g, 4 yo, Santa Anita Park, MCL, 4/7, 6f, 1:12.55, $22,200.
Prospect Park—Bert's Melody: Bert's Prospect (13-4), g, 4 yo, Santa Anita Park, MSW, 4/19, 1mi (T), 1:34.68, $32,400.
Sir Prancealot (IRE)—Hallelujah Girl: Hallisar (31-10), g, 3 yo, Golden Gate Fields, MCL, 3/29, 6f, 1:12.31, $7,800.
Sir Prancealot (IRE)—Sheeza Sassy Girl: We Can (31-10), g, 3 yo, Golden Gate Fields, MCL, 3/29, 1mi, 1:39.77, $6,300.
Sir Prancealot (IRE)—Shes a Real Keeper: Keepyourpranceon (31-10), f, 3 yo, Golden Gate Fields, MCL, 4/20, 5 1/2f, 1:05.17, $7,800.
The accompanying list includes runners that are both California-foaled and Californiasired winners in 2023 of all recent North American races, except straight claiming races. Abbreviations used for the class of race are similar to those used by Equibase: Alw–allowance; Hcp–overnight handicap; names of stakes race are spelled out, with the grade of the race, when applicable, in parentheses.
Sky Mesa—Shortbread Scotty: Rollin Dice (64-18), g, 3 yo, Golden Gate Fields, MCL, 4/20, 5 1/2f, 1:04.75, $7,800.
Slew's Tiznow—Pillow Pal: Timely Comfort (8-3), g, 4 yo, Golden Gate Fields, MCL, 4/7, 5 1/2f, 1:05.13, $6,300.
SMILING TIGER
Harris Farms (800) 311 6211 www.harrisfarms.com
Smiling Tiger—Fragrant Harbor: Smile and Profle (84-27), f, 4 yo, Golden Gate Fields, MCL, 4/5, 1mi, 1:40.08, $6,300.
Smiling Tiger—Magic School: Bit's Tiger Magic (84-27), f, 3 yo, Santa Anita Park, MSW, 4/7, 6f (T), 1:08.90, $39,000.
Smiling Tiger—Cultural Icon: Santaluz Dream (84-27), f, 3 yo, Turf Paradise, MCL, 4/16, 1mi, 1:38.78, $7,200.
Sporting Chance—Fast Gator: Cash Follows Me (10-1), g, 3 yo, Sunland Park, MCL, 3/29, 5f, 58.41, $7,980.
STANFORD Harris Farms (800) 311 6211 www.harrisfarms.com
Stanford—Tizwellwithmysoul: Beat of My Heart (61-25), f, 3 yo, Golden Gate Fields, MCL, 3/29, 5 1/2f, 1:05.35, $7,800.
TEXAS RYANO Arroyo Vista Farm 760 913 5052 www.arroyovistafarm.com
Texas Ryano—Lauren's Export: Longhorn Lassie (9-3), f, 3 yo, Los Alamitos, MCL, 4/6, 4 1/2f, 52.20, $4,455.
Texas Ryano—American Tribe: Fifty Stars (9-3), f, 3 yo, Sunray Park, MCL, 4/14, 6 1/2f, 1:20.70, $6,750.
Tom's Tribute—So Golden: Fayruz Tribute (9-4), g, 4 yo, Golden Gate Fields, MCL, 3/29, 1mi, 1:40.56, $7,200.


MIDDLE-AGED AND OLDER HORSES ARE ESPECIALLY SUSCEPTIBLE
BY HEATHER SMITH THOMASEquine asthma was one of the frst respiratory diseases described in veterinary literature—a recurring, non-infectious syndrome that impairs respiratoryfunctionbycausingcongestion and constriction of airways. Tisisgenerallytheresultofbreathing aerosolized debris that contains particles like mold or pollen.
Traditionally called “heaves” or “broken wind,” this disorder has undergone multiple medical name changes that include chronic obstructive pulmonary disease (COPD) and recurrent airway obstruction (RAO) as understanding of the disease evolved. Recent fndings indicate that afected horses have much in common with human asthmatics, resulting in another term: equine asthma.
Virginia Buechner-Maxwell, DVM, MS, Diplomate ACVIM, a professor of large animal internal medicine at the Virginia-Maryland Regional College of Vet-
erinary Medicine in Blacksburg, Va., says this disease most often afects middle-aged or older horses and is not an infection.
“Past research indicated that asthmatic horses mainly reacted to factors found in a barn environment, such as exposure to hay that contains the common mold Aspergillus fumigatus,” Buechner-Maxwell said. “More recently, variations have been recognized. Particles found in a pasture, like tree pollens or other plant matter, can initiate breathing difculty.”
Te causative agent is horse-specifc.
“Generally, the best way to determine
what causes this response is through trial and error, and carefully observing the events that precede the onset of an event,” she said.
“While heaves is not curable, afected horses can live long and productive lives. Te key is to learn how to manage the horse in ways to minimize exposure to factors that provoke the disease.
“It is important to detect early signs associated with exacerbation of the disease, and react quickly with a change in environment, along with administration of medication when needed,” Buechner-Maxwell said. “When affected horses are untreated, persistent infammation in the lungs may prime them to be more reactive to other elements in the barn or pasture.”
Studies also show that long-term infammation can have lasting negative and irreversible changes in the structure of the airways.
“Tere may be primary factors that initiate the event,” Buechner-Maxwell said, “and once the lungs become infamed, they become more sensitive and reactive, allowing secondary elements to exacerbate the problem and the horse becomes more compromised.”
For example, a horse might be allergic to a particular mold in hay and develop an acute episode of heaves. Once the lung is infamed, other things—like dust—exacerbate it.
“Te frst step is to break the cycle and get the horse into full remission,” Buechner-Maxwell said. “Horses can appear normal, but still have smoldering airway infammation. Residual airway infammation makes the horse more prone to recurring episodes because the underlying problem (airway infammation) has not been resolved. Full remission means the horse is clinically normal and the airway infammation has resolved.”
Sometimes if you can get the horse back to normal and eliminate the primary factors, the horse can better tolerate other elements in the environment.
“Fifteen years ago, we did a study comparing three diferent treatments for heaves,” Buechner-Maxwell said. “One was signifcant change in the environment aimed at reducing any source of


aerosolized dust and debris. Te second was a change in environment along with treatment with dexamethasone, and third was just dexamethasone. Te study showed that changing the environment to eliminate debris worked as efectively as putting the horse on corticosteroids and changing the environment. Changing the environment was the safest and best way to manage these horses.”
Te frst principle of treatment is to eliminate the cause.
“Examine the environment to see how you can improve it for that horse, so inhaled debris is minimized,” said Buechner-Maxwell.
Some of the worst places for some hors-
es can be a barn, being fed dusty hay above the level of the horse’s nose or being stalled next to an area where there’s a lot of dust.
Examine each fake of hay fed and discard any that are moldy or dusty.
Feeding hay below the level of the horse’s chest is better than using an overhead hay net or feeder, so that hay debris doesn’t drop into the nostrils.
“For some horses, round bales are a risk for initiating or escalating an episode of severe heaves,” said Buechner-Maxwell. “Many people use big, round bales as an efcient way to feed a group of horses. But if a horse with heaves buries his nose in the hay, he is constantly breathing dust particles.”
Wetting hay may reduce exposure to aerosolized mold spores. Sprinkling the hay may temporarily settle dust, but a thorough soaking may be necessary to eliminate dust and air-borne particles.
“Soaking hay may reduce nutrient value of the hay, however,” Buechner-Maxwell said. “A newer method for minimizing mold is steaming hay,” A good hay steamer moisturizes hay while substantially reducing fungal load.
If the horse spends time in a barn, managing the stall to minimize dust can help, but not if the horse next door is fed hay or has dusty straw for bedding. Te entire barn must be managed to minimize dust. Even if hay is stored at the other end of the barn, this may be enough of a trigger for a sensitive horse. Ammonia may also be an issue.
Changing the environment is an essential frst step, but in some cases the horse’s respiratory function is so severely compromised that medication may be necessary. Two types of medications are commonly used to relieve signs of asthma in horses.
“Tese are corticosteroids—drugs that ‘turn down’ the immune response and decrease swelling and infammation— and bronchodilators that open up the air passages,” Buechner-Maxwell said. “Tese medications can be delivered directly into the horse’s airways or can be given by injection or orally.
“Often by the time an asthmatic horse is admitted to our clinic, its breathing is severely compromised. We put them in areas in the clinic that are air-conditioned and we can keep the dust low. We also use medications.
“In hospitalized patients, these medications are often delivered using a nebulizer or airway delivery device. Most inhaled medications are chemically designed so minimal amounts get into the bloodstream and afect other organs in the body. Teir efect is mainly localized to the target organs—the lungs. Tere are also forms of these medications that can be delivered by injection into the blood or using the oral route.
“One serious, unintended outcome of systemic corticosteroid administration can be laminitis, so we try to avoid providing systemic corticosteroids when treating severe asthma cases, because higher doses are usually required to get the problem under control. In most cases, once the environment has been cleaned up and the horse can breathe, doses of these medications can—and should—be reduced to the lowest dose that maintains remission from asthma. Once the horse reaches this phase, transition to other forms of medications (oral or injectable) is less risky, but they still have a systemic efect that can produce negative outcomes.
“Years ago, providing nebulized medications to horses with respiratory disease was mainly done in a referral hospital environment, or in stables where more intense management was possible (like racing training barns). More recently, nebulizers designed for use in horses have come on the market. Tere are several available, and we’ve used most of them at our clinic. Designs have undergone further improvement over the years.
“Te one I use is a mask that fts over the muzzle. All material for nebulization is contained within the mask. It has a battery-operated nebulizer system that flls the mask with the medication the horse subsequently inhales. It’s easy to put this on the horse, and most are accepting of the apparatus and treatment. In some cases, horses stand so quietly with the mechanism in place that a person can work nearby until it’s time to take it of. Te medication is delivered in about 15-20 minutes, once or twice a day, depending
In general, we use corticosteroids in asthmatic patients to reduce infammation in the lung, turning of or tuning down the immune response.”
—Dr. Virginia Buechner-Maxwell
on what the horse needs.”
If you don’t want the risk of using systemic corticosteroids, this is a good way to manage some of the clinical problems with heaves.
“It is a lot safer,” Buechner-Maxwell said. “You can use medications that concentrate in the lungs rather than giving them orally and having them go through the whole body. Te upfront cost of the nebulizer can be expensive, but some of the medications that are delivered by nebulization are fairly inexpensive. Te nebulizer can also be used if a horse has a lung infection, to nebulize antibiotics, and other helpful therapies as well.”
Corticosteroids decrease swelling and infammation. Systemic corticosteroids are usually given by mouth or injection. Examples include dexamethasone and prednisolone.
“Dexamethasone is about 10 times more potent than prednisolone,” Buechner-Maxwell said. “Either drug should only be given under a veterinarian’s guidance since they can cause signifcant side efects. Both come in tablet form that can be given in a small amount of grain and are relatively inexpensive. In some cases, injectable formulations can be administered orally and are nearly as efective.
“Oral prednisone is often used to treat infammatory problems in cats and dogs, but is not efective in horses due to diferences in the horse’s ability to metabolize the drug into an active form. Diferent drug effects can vary from species to species.
“A commonly used inhaled form of corticosteroid is futicasone, which has been chemically modifed so it only remains active in the lung. Once it enters the blood, circulating enzymes rapidly degrade it, reducing the risk of systemic side efects. Tis drug was originally designed to treat pediatric patients with the goal of minimizing side efects in growing children. It is more expensive than orally administered corticosteroids, especially when using the metered dose (inhaler) formulations.
“In general, we use corticosteroids in asthmatic patients to reduce infammation in the lung, turning of or turning down the immune response to what the horse is reacting to. Tis is the best way to reverse the clinical signs—the horse breathing hard, coughing, etc. Te only way to shut this down is to try to eliminate what is causing the reaction, but sometimes it requires adding corticosteroids to get it back under control.
“When horses are in remission, not showing clinical signs, you can often use a much lower dose of corticosteroids to control heaves, as opposed to when they are in crisis and having trouble breathing. You have to start with higher doses and then wean them down. Te goal is to get to the lowest possible dose and lowest frequency (such as every-other-day treatment) that will still
In 2012, Dr. Virginia Buechner-Maxwell and a graduate student, Dr. Celeste Blumerich, conducted a study on a HAYGAIN steamer. Six horses with a history of heaves, ranging in age from 14 to 25, were divided into two groups of three horses each.
They were housed and fed hay for a 10-day period. During the frst part of the study, Group A horses were fed free-choice grass hay, and Group B was fed the same hay after steaming.
“During the 10-day period, a physical examination was performed daily on all horses, using a scoring system to keep track of any signs that the horses were developing heaves,”
Buechner-Maxwell said. “Evidence of airway infammation was gathered by assessing the amount of mucus in the
keep the horse comfortable.”
Bronchodilators can also help, since infammation causes airways to constrict.
“Tese drugs open the airways, but won’t fx the problem,” Buechner-Maxwell said. “Te infammation is still there; bronchodilators simply relieve symptoms by allowing the horse to breathe easier.”
Two that are commonly used are clenbuterol and ipratropium.
“Clenbuterol is a beta-2 agonist, and most efective after you’ve already started a horse on corticosteroids,” Buechner-Maxwell said. “Infammation tends to block some of the response to clenbuterol.
“Ipratropium bromide is similar to atropine, so it could create serious problems if given systemically. Atropine will cause the gut to shut down, and ipratropium would probably do the same. Te way we deliver it is through an inhaler or nebulizer, and most of it concentrates in the lung rather than getting into the gut. Ipratropium is used in humans for asthma and is very efective.”
New medications include a new product, produced by Boehringer Ingelheim, called Aservo® Equihaler® that can help horses.
“Even though it is a corticosteroid, which can have some negative efects if given orally, the drug they use in this product is activated into a corticosteroid efect only when it lands on the lining of the airways,” Buechner-Maxwell said.
horses’ tracheas and measuring the amount and types of infammatory cells in their airway secretions.
“The amount of food and water consumed was also measured daily, and body weights recorded at the start, middle, and end of the 10-day period. After the frst part of the study was complete, the horses were all turned out on pasture for three weeks, then returned to the barn for a second 10-day period.”
During the second part of the study, the diet was switched. Group B horses were fed the dry hay and Group A horses were fed steamed hay. All other parts of the study remained the same.
“The ones fed steamed hay showed less clinical signs and developed less airway infammation than when they were fed un-steamed hay,”

“Tey did a lot of testing and found it is not signifcantly taken up in the bloodstream. Tis is measured by looking at the normal production of corticosteroids by the body. Usually when you give dexamethasone, it suppresses the body’s own production, and this drug does not.
“Tis is very positive, especially for horses that mingle with a lot of other horses, such as at the racetrack. Tey need a strong immune system (not hindered by steroids). Usually they are well vaccinated, but vaccines depend on the immune system to function well, to be efective.
“Also, racehorses put a lot of stress on their feet. If they were to develop laminitis, it would probably be the end of their career. Tis drug is less likely to increase the risk for laminitis and has minimal effect on the immune system.
“I work with a lot of heavey horses, and
Buechner-Maxwell said.
“We sampled the hay before and after steaming, using a core drill. One of our fungal experts here at Virginia Tech helped me test the samples for fungal growth. It was amazing to see how much the steaming reduced the growth, if you get it up to the right temperature. In three days of culture, we saw almost no fungal growth in samples containing the steamed hay. By contrast, fungi grew immediately in un-steamed hay. These fndings show that steaming can reduce the amount of active fungi in hay
“Steaming gets the core temperature up to 212 degrees. This seems to eliminate or greatly reduce microbes. You are not just wetting the hay, but also reducing the load of molds and fungi such as aspergillus.”
for some of them this drug works very well. It’s not a substitute for cleaning up the environment and minimizing exposure to inhaled debris, but in an improved environment I’ve seen many horses do very well with this product.
“Boehringer Ingelheim has also developed a very efective delivery system. Te medication comes in a package that includes the Equihaler. Te nasal apparatus inserts into the nose, and horses tolerate it very well. Te plastic apparatus has a little handle so you can activate and administer a dose for the horse to inhale.
“You deliver a series of activation that usually takes less than a minute, once a day. After the environment is changed, horses can often manage with a lower dose.”
Finding the right combination of environmental changes and medications may require patience. And not all medications have the same efect on every horse.
“I think that’s because asthma and heaves are just umbrella terms for multiple problems, but these horses, when managed well, can live long and useful lives,” Buechner-Maxwell said. “When I was in my late teens, I bought a horse that developed asthma when he was 7, and lived to be 37. He continued to be useful into his early 30s. Not all asthmatic horses will do this well, but many do if they are managed in a way that prevents severe asthmatic episodes.”
Sire
1 Clubhouse Ride, 2008, by Candy Ride (ARG)
2 Pavel, 2014, by Creative Cause
3 Square Eddie, 2006, by Smart
4 Grazen, 2006, by Benchmark
5 Acclamation, 2006, by Unusual Heat
6 Empire Way, 2009, by Empire Maker
7 Mr. Big, 2003, by Dynaformer
8 Sir Prancealot (IRE), 2010, by Tamayuz (GB)
9 Smiling Tiger, 2007, by Hold That Tiger
10 Danzing Candy, 2013, by Twirling Candy
11 Lakerville, 2008, by
12
13
14
15
16
1 Clubhouse Ride, 2008, by Candy Ride (ARG)
2 Grazen, 2006, by Benchmark
3
4
5 Acclamation,
6 I’ll Have Another, 2009, by Flower Alley
7 Sir Prancealot (IRE), 2010, by Tamayuz (GB)
8 Midnight Storm, 2011, by Pioneerof the Nile
9
12
1 Pavel, 2014, by Creative Cause
2 Lakerville, 2008, by Unusual Heat
3 Gig Harbor, 2008, by City Zip
4 Idiot Proof, 2004, by Benchmark
5 Misremembered, 2006, by Candy Ride (ARG) 22
6 Curlin to Mischief, 2011, by Curlin
7 Acclamation, 2006, by Unusual Heat
8 Tamarando, 2011, by Bertrando
9 Far From Over, 2012-21, by Blame
10 Desert Code, 2004, by E Dubai
11 Mr. Big, 2003, by Dynaformer
12 Bold Chieftain, 2003, by Chief Seattle
13 Grazen, 2006, by Benchmark
14 Straight Fire, 2014, by Dominus
15 Cat Burglar, 2010, by Unbridled’s Song
16 Conquest Farenheit, 2014, by Scat Daddy 11
17 Many Rivers, 2005, by Storm Cat 12 8 $78,670 $6,113
18
20
1 Clubhouse Ride, 2008, by Candy Ride (ARG)
4 Sir Prancealot (IRE),
5 Square Eddie,
6
7
8
Stallion (Foreign Foaled), Year, Sire
1 Grazen, 2006,
2 Clubhouse Ride, 2008, by Candy Ride (ARG)
3 Mr. Big, 2003, by Dynaformer
4 Vronsky, 1999, by Danzig
5 Bluegrass Cat, 2003, by Storm Cat
6
7 Sir Prancealot (IRE), 2010, by Tamayuz (GB)
8 Majestic Harbor, 2008, by Rockport Harbor
9 Street Hero, 2006, by Street
25 Big Bad Leroybrown, 2004, by Wild Again
James Street, 2007, by El Prado (IRE)
34 Bold Chieftain, 2003,
36 Rousing Sermon, 2009, by Lucky Pulpit
38 Dads Caps, 2010, by Discreet Cat
39 Fullbridled, 2001, by Unbridled’s Song
40 Gig Harbor, 2008, by City
41 Golden Balls (IRE), 2004, by Danehill Dancer
46
These statistics are for active California-based sires with a minimum of 50 foals of racing age, ranked here by their lifetime Average Earnings Index (AEI.) The statistics shown here are compiled by The Jockey Club Information Systems (TJCIS). While every effort is made to prevent errors and omissions, California Thoroughbred cannot guarantee their complete and total accuracy. Sires that are dead, pensioned, or no longer standing in California remain on these lists until their last Cal-bred crop turns 3 years old. Statistics are from all available Northern Hemisphere racing with earnings adjusted for Hong Kong and Japan. Stakes winners and wins follow TJCIS stakes rules. Percentages are based upon number of named foals of racing age.
Santa Anita Park, Arcadia
Dec. 26, 2023-June 16, 2024
Golden Gate Fields, Berkeley Dec. 26, 2023-June 9, 2024
Pleasanton, Alameda County Fair, Pleasanton June 14-July 7
Los Angeles County Fair at Los Alamitos, Los Alamitos June 19-July 9
Del Mar Thoroughbred Club, Del Mar July 20-Sept. 8
California State Fair (Cal Expo), Sacramento July 12-28
Sonoma County Fair, Santa Rosa July 31-Aug. 20
Humboldt County Fair, Ferndale
Aug. 23-Sept. 8
Los Alamitos Race Course, Los Alamitos Sept. 11-24
Santa Anita Park, Arcadia Sept. 25-Oct. 29
Big Fresno Fair, Fresno
Sept. 21-Oct. 14
Pleasanton, CARF Combined Fair Meet Oct. 16-Dec. 25
Del Mar Thoroughbred Club, Del Mar Oct. 31-Dec. 1
Los Alamitos Race Course, Los Alamitos Dec. 4-17

AUGUST 13
CTBA NORTHERN CALIFORNIA
YEARLING & HORSES OF RACING AGE SALE
Pleasanton, Calif.
(ENTRIES CLOSE MAY 31)
SEPTEMBER 24
FASIG-TIPTON FALL YEARLINGS & HORSES OF RACING AGE
Pomona, Calif.
(ENTRIES CLOSE JULY 5; SUPPLEMENTAL ENTRIES CLOSE SEPT. 9)
SANTAANITA
SATURDAY, MAY 25
$100,000 Crystal Water Stakes Tree-Year-Olds & Up 1 mile (Turf)
$100,000 Fran’s Valentine Stakes Tree-Year-Olds & Up, Fillies & Mares 1 mile (Turf)
SATURDAY, JUNE 15
$75,000 Mary Clare Schmitt Stakes Tree-Year-Olds & Up, Fillies & Mares 6 f.
FRIDAY, JULY 26
$150,000 Fleet Treat Stakes Tree-Year-Old Fillies 7 furlongs

– TRAINING AND LAY-UPS TRANSPORTATION ANYWHERE IN THE US. 31101 HWY 166, MARICOPA CA. 93252
RAMON GONZALEZ –(661) 699-5527
SPECIALIZING IN NORTHERN CALIFORNIA HORSE RANCHES BIG OR SMALL PLEASE GIVE ME A CALL.
ROBIN HAS BEEN SELLING EQUESTRIAN PROPERTIES FOR OVER 25 YEARS.
PLEASE CALL ROBIN AT (925) 550-2383 OR EMAIL AT ROBIN FROST1@YAHOO.COM
WWW.ROBINSRANCHES.COM AGENT BRE #01039978


















I. A $15,000 bonus will be made available for owners of registered CaliforniaBred or California-Sired maidens in Maiden Special Weight races at Santa Anita and Del Mar, and a $10,000 bonus for owners of registered CaliforniaBred or California-Sired maidens in Maiden Special Weight races at Los Alamitos and all Northern California meets. Only races at 4 1/2 furlongs or longer will qualify. In the event of a dead heat, the bonus will be split amongst the winners.
II. Significant eligibility changes for California-breds.
©Benoit



